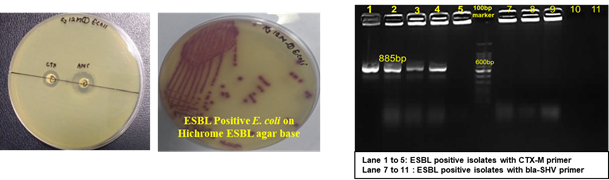
Image of Prevalence of ESBL positive E. coli in milk

Dairy Microbiology
Dairy Bacteriology Division was established in 1940 at the Imperial Institute of Animal Husbandry and Dairying at Bangalore under the stewardship of Dr. W. L. Davies as the first Director of the institute. Dr K. K. Iya, an eminent dairy scientist became Dairy Bacteriologist and Head of the Division in 1948. After independence, the Imperial Institute was named as National Dairy Research Institute and was shifted to Karnal in 1955. The Division has been instrumental in contributing significantly in both basic as well as applied aspects of Dairy Microbiology.
The major objectives of the Division are as follows:
- To serve as a center of excellence for carrying out basic and applied research in different areas of Dairy Microbiology both at the level of milk production and processing.
- To provide technical support and consultancy to dairy industry in all the areas related to microbiological aspects of milk and milk products and their value addition through intervention of micro-organisms for improving health and nutrition along with their safety and quality.
- To conduct teaching programme at UG and PG level for NDRI Deemed University.

Father of Nation at Dairy Microbiology Division
The Division is currently engaged in research, teaching, consultancy, training and technology transfer in specialized field of Dairy Microbiology. Broadly, the research work of the division covers the areas related to starter cultures and fermented milk products; direct vat starters (DVS); indigenous probiotics, their functional efficacy and gut microbiota, prebiotics and synbiotics; diversity of traditional fermented milk products by metagenomic, metabolomic and culturomic approaches, bioactive peptides, microbial metabolites and bio-preservatives; biosensors, quality assurance and food safety. The Division has played a key role in establishing National Collection of Dairy Cultures’ (NCDC) with current repository of more than 800 cultures and National Referral Centre for Milk Quality and Safety. The Division has transferred technologies on two indigenous strains of probiotics, Misti Dahi, rapids kits for antibiotic residues, Listeria monocytogenes and Enterococci to potential stake holders in our country for their industrial application. Few more such products like vitamin B12 rich propioni-yoghurt, blueberry fortified probiotic dahi, real time test for detection of E. coli and antibiotic residues in milk have been developed and are under process of validation for their commercialization.
The faculty is also involved in imparting teaching and guidance for both under-graduate and post-graduate programmes. The Division offers M. Tech and Ph.D programmes in Dairy Microbiology as well as Food Safety and Quality Assurance. Besides, Division is also contributing in teaching Microbiology courses to B. Tech (Dairy Technology) students. Division also offers contractual and consultancy/training services such as supply of starter cultures, freeze-drying of cultures, microbiological analysis and setting standards for regulatory compliance of dairy products in our country. Division regularly organizes need based specialized short term symposia/ conferences/seminars covering basic and applied areas of dairy microbiology including quality assurance, food safety, starter cultures and fermented health foods for HRD development in our country.
Welcome to the Department of Dairy Microbiology at ICAR-National Dairy Research Institute, Karnal. Dairy Microbiology is one of the oldest departments which took birth when Dr. K.K.Iya who was the first Dairy Bacteriologist joined as the Director of this premier Institute. The department was blessed with the Chairmanship of Dr. Dudani way back in 1959 followed by the leadership of several stewards. We started our journey from preliminary research projects for determination of microbiological quality of milk and milk products, dahi and presently in new frontier areas of science including molecular biology. The objective of department is to empower our students with latest technical knowledge and skills by grooming them with the best teaching, providing them with state of the art research facilities and to work on excellent research projects and publish in high impact journals besides commercializing technologies and filing patents.

Dr. Shilpa Vij, HOD
We have an everlasting tradition of educational excellence in training and nurturing the finest microbiologists both for industry and academics. At present, we are offering Post graduate programmes M. Tech/M.Sc and Ph.D both in Dairy Microbiology and Food Safety and Quality Assurance. Our faculty is also involved in teaching B. Tech (Dairy Technology) students. Undergraduate students are also encouraged to work on small projects in different research labs. Our department also hosts international students under Khurana, RTF-DCS, INSA-JRD TATA and DBT-TWAS Post Doctoral programmes, and provides training to students from other universities. The focus of our academic programmes is to make students ready to take up jobs in dairy industries especially in Quality Control labs as well as imparting technical know-how in several research areas, promote their problem solving skills to pursue Doctrate and post doctoral programmes within and outside India and development of innovative technologies. The students are provided hands on training in all the latest techniques. We update our course contents regularly to introduce new scientific and technological developments. Recently, we have been instrumental in development of “National referral center on milk Quality and safety” with the funding to the tune of 17.5 lakhs. NRC has world class facilities, NABL accredited and has become a platform for conducting research by students of FSQA.
Our faculty is very active in winning grants and we have several externally funded projects supported by DBT, DST, ICMR, MoFPI, ICAR etc. Funding support for research from various bodies helps us to develop infrastructural facilities for conducting research in latest areas of Microbiology. Our department also carries out collaborative and interdisciplinary research projects both at National and International level. At International level, we have collaborations with South Africa, Brazil, New Zealand, ILRI and UK and at National level, we have collaborations with NICED, AIIMS, PGI, Tezpur University, Palampur, AAU etc. Our department is in the fore front to commercialize several technologies to industry as well as in terms of patents. We have state of the art research facilities like Molecular Biology Unit, Electron Microscopy lab, National Referral Centre, National Collection of Dairy Cultures etc. to support our academic programmess and research.
Our department has a distinguished track record in both teaching and research. Faculty members have excellent academic credentials and are highly reputed. They have been conferred with many prestigious awards at national level like Rafi Ahmed Kidwai award, Young Women Bioscientist award, Best Teacher awards etc. Our department has the privilege of having four fellows and one associate of prestigious National Academy of Agricultural Sciences. Several faculty members also serve on the editorial boards of national and international journals, reviewer for journals of high impact factor and organize international symposia and conferences and member of various task forces and scientific bodies at FSSAI, DBT, DST etc. We, the faculty members, all work as team to take our department to new heights of success and glory. As a former student of this Department of Dairy Microbiology, I feel proud to be the part of the department for producing world class professionals, administrators and researchers. It is the dedicated efforts of all our faculty and stalwarts of DM division since its inception that department has made tremendous achievements in the area of Dairy Microbiology.
We hope that after browsing our web pages, you will find our department a unique place to work and study to nurture your professional dreams and a rewarding career as Dairy Microbiologist. Please do not hesitate to contact us if you have any queries. We welcome you to correspond to any of our faculty members directly by E mail given on faculty pages. We welcome the suggestions, if any, for improvement which is dynamic. We thank you for visiting us.
| Sr. No. | Faculty Name | Designation |
|---|---|---|
| 1 | Dr. Anil Kumar Puniya | Principal Scientist |
| 2 | Dr. Pradip Behare | Scientist (SS) |
| 3 | Dr. Chand Ram Grover | Principal Scientist |
| 4 | Dr. Rashm H. M | Scientist |
| 5 | Dr. Raghu H. V. | Scientist (Senior Scale) |
| 6 | Mr. Saurabh Kadyan | Principal Scientist |
| 7 | Dr. Naresh Kumar | Principal Scientist |
| 8 | Dr. Diwas Pradhan | Scientist |
| 9 | Dr Shilpa Vij | Principal Scientist |
International Collaboration
- University of Pretoria, South Africa, UCARS, Brazil
- BBSRC – Biotechnology and Biological Sciences Research Council, UK
- Riddet Institute University Ave, Massey University, Palmerston North 4474, New Zealand
- International Livestock Research Institute (ILRI)
National
- Tezpur University
- National Institute of Cholera and Enteric Diseases (NICED)
- CSIR-National Chemical Laboratory (NCL)
- University of Delhi
- TERI – The Energy and Resources Institute
- CSRI-Central Food Technology Research Institute (CFTRI)
- Indian Veterinary Research Institute (IVRI)
- National Research Centre (NRC) on Yak
- National Institute of Animal Nutrition and Physiology (NIANP)
- National Research Centre on Equines
- State Agriculture Universities (SAU’s)
- Sikkim University, Gangtok
- National Bureau of Agriculturally Important Microorganisms, Mau
- SMC College of Dairy Science, Anand Agricultural University, Anand
Heads of Dairy Microbiology Division, Karnal.

Dr KK Iya.
The first Dairy Microbiologist

Dr. A.T. Dudani
(1959-67)

Dr. H. Laxminarayan
(1967-71)

Dr. B. Ranganathan
(1971-78)

Dr. R.A. Srinivasan
(1978-81)

Dr. R.S. Singh
(1981-84)

Dr. D.N. Prasad
(1984-87; 1997-2001)

Dr. D.K. Mathur
(1987-90, 1995-97)

Dr. S. Neelkanthan
(1990-94)

Dr. R.N. Sinha
(1994-95)

Dr.V.K.Batish
(2002-2009)

Dr. Rameshwar Singh
(2010-2012)

Dr.Ravinder Kumar Malik
(2012-2014)
History of Dairy Microbiology Division
The research in Dairy Microbiology started way back in 1935 at Imperial Institute of Animal Husbandry and Dairying at Bangalore under the leadership of Dr. C.S.Ram Ayyar, who was essentially a chemist. He carried out some research on Methylene Blue Reduction test on milk and dahi cultures. Later, Dr. W. D. Davies who assumed the charge of Director in 1939 was very keen to strengthen research in Dairy Microbiology. Dr. K.K.Iya, the first Dairy Bacteriologist joined the institute at Bangalore as a Honorary Research Worker in 1939 for three months to study bacteriology of dahi under Dr. Ayyar. Thereafter, Dr Acharya joined the Institute as Research Dairy Bacteriologist in 1940, but unfortunately died prematurely at a young age. Meanwhile, Dr. H. Laxminarayana on his own persistent efforts transferred himself from the then comfortable position of P.A to Imperial Dairy Expert to start learning bacteriology and the main focus was on dahi since it was believed that dahi is related to microbial activity. Bangalore Dairy Institute was the only centre in India for dairy microbiology research and a systematic programme of research started functioning there only around 1949-50.
The research programme in Dairy Bacteriology at Karnal could start only after the National Dairy Research Institute was established in 1954-55 and the post of Dairy Bacteriologist (Head of Division) was transferred from Bangalore in 1955. The Division could really start its research programme in 1962 when facilities of staff, equipment and buildings became available to meet the needs of this Division. The first Head of Division was Dr. A.T. Dudani (1959-1967). Most of the young research workers in bacteriology Division at Bangalore obtained their Masters and Doctorate degree entirely by submitting a research thesis on a problem in Dairy Bacteriology. This led to collection of a fairly comprehensive volume of data on the different major groups of microflora in milk, their incidence under rural and urban conditions of milk production and handling source, their activities and influence on the keeping quality of milk and milk products and effect of dye reduction tests mainly Resazurin and tetrazolium etc. The work on starter cultures and dahi was intensified also.
After the Division of Dairy Bacteriology started functioning effectively at Karnal, a significant change in the research programme was brought about that involved studying the metabolic pathways of lactic acid bacteria involved in diacetyl production using radio-active isotopes, Freeze drying of lactic starters, bacterial and fungal enzymes for coagulation of milk for cheese making as rennet substitutes. The studies on Nisin production and bacterial genetics were also initiated. The various aspects of fundamental and applied aspects of dairy bacteriology were taken up for intensive research at Dairy Bacteriology Division, Karnal that developed into a full-fledged centre of research with active research scientists who had well equipped facilities and adequate financial support. Supporting organization ICAR contributed much to stimulate research in this important field.
Clean milk production, and dahi making were taken for investigations for the rural people. National Dairy Research Institute had the operational research programme to develop programmes of work that would benefit the rural people most. The work on H2O2 and its preservative action on milk was started. When this work was first started in 1950 or so, extremely encouraging results were obtained and by 1953-54, the Dairy Bacteriology Division at Bangalore was ready with recommendations for Government to approve the use of this method on a wide scale. However, there was great fear that the method would be misused by unscrupulous persons endangering the health of vast numbers of consumers. Even FAO did not take to the use of this method and in 1957 an FAO Expert group. Later, NDRI and NDDB jointly tackled this problem to use H2O2 for preserving milk at low cost without danger to consumers.
Later, Dr. H. Laxminarayana took over the charge of Head, Dairy Bacteriology in 1967 followed by Dr. B. Ranganathan in 1971 till 1978. The position of Head was started on rotation basis for a period of three years which was first taken up by Dr. R.A. Srinivasan (1978-1981) followed by Dr. R.S. Singh (1981-1984), Dr. D.N. Prasad (1984-1987), Dr. D.K. Mathur (1987-1990), Dr. S. Neelakanthan (1990-1994), Dr. R. N. Sinha (1994-1995) and again by Dr. D.K.Mathur for 1995-1997. The post of Head of Dairy Microbiology Division was advertised and selection was on the basis of interview and Dr. D. N. Prasad joined for a period of five years from 1997-2002. Dr. V. K. Batish took the charge of Head of DM Division in 2002 till 2009 followed by Dr. Rameshwar Singh (2010-2012) and Dr. R.K.Malik (2012-2014). Dr. Sunita Grover assumed the office of Head, Dairy Microbiology Division in August, 2014 and is continuing presently as Head. Under the dynamic leadership of all the stalwarts in Dairy Microbiology, division has made tremendous progress in the area of Dairy Microbiology starting from simple to advanced research including Molecular Biology and Biotechnology.
Dairy Microbiology Division contributed a lot in initiating Biotechnology research at NDRI. Biotechnology was initiated at NDRI, Karnal during mid eighties under a UNDP ‘Centre of Excellence on Biotechnology’ programme and strengthened by funding from Department of Biotechnology and National Agricultural Research Project-II. Drs. S. Neelakantan and V.K.Batish from Dairy Microbiology Division were entrusted with the responsibility to carry out research in the area of Dairy Processing Biotechnology and to initiate Masters in Animal Biotechnology at NDRI. Under this programme, Molecular Biology Unit was also established.
Dairy Microbiology Division was also entrusted with the responsibility of establishing National Referral Center on Milk Quality and Safety (NRCMQS) with financial support from World bank under NAIP project of 17.5 Crores in 2014 for addressing the scientific issues on milk safety in our country and quality assurance; to carry out Risk Profile on potential contaminants in milk and milk products; development of milk safety standards, sampling plan and testing procedures for regulatory compliance; Rapid Biosensor Based Tools/Assay/Kits for field application and to conduct training on HRD development on milk quality.
Academic Programmes offered in Dairy Microbiology Division
- Tech (Dairy Microbiology)
- Ph. D (Dairy Microbiology)
- Tech (Food Safety and Quality Assurance)
| B Tech DT | ||
|---|---|---|
| Course No. | Course Title | Credits |
| I SEM | ||
| DM -111 | Fundamentals of Microbiology | (2+1) |
| DM- 311 | Quality and Safety Monitoring in Dairy Industry | (2+1) |
| II SEM | ||
| DM -121 | Microbiology of Fluid Milk | (1+1) |
| DM -221 | Starter Culture and Fermented Milk Products | (2+1) |
| DM -222 | Microbiology of Dairy Products | (1+1) |
| DM -321 | Food and Industrial Microbiology | (2+1) |
| M. Tech DM | ||
|---|---|---|
| Course No. | Course Title | Credits |
| I SEM | ||
| DM-611 | Microbial Morphology and Taxonomy | 2+1 |
| DM-612 | Microbial Physiology | 2+1 |
| DM-613 | Microbiology of Fluid Milk and Dairy Products | 2+1 |
| DM 614 | Environmental Microbiology | 2+1 |
| DM-615 | Microbiology of Processed Dairy Foods | 2+1 |
| II SEM | ||
| DM-621 | Starter cultures and Fermented Dairy Products | 2+1 |
| DM-622 | Microbial Genetics | 2+1 |
| DM-623 | Microbiological Quality Assurance | 2+1 |
| DM-624 | Probiotics for Health Foods | 2+1 |
| DM-625 | Research Techniques in Dairy Microbiology | 2+1 |
| DM-626 | Microbial Fermentation Technology | 2+1 |
| DM-629 | Credit seminar | 1+0 |
| Ph.D DM | ||
|---|---|---|
| Course No. | Course Title | Credits |
| I SEM | ||
| DM- 711 | Microbial Diversity and Physiology | 3+0 |
| DM- 712 | Advances in Microbial Genetics | 3+0 |
| DM-719 | Credit seminar | 1+0 |
| I II SEM | ||
| DM -721 | Advances in Dairy and Food Microbiology | 3+0 |
| DM -722 | Advances in Food Safety of Dairy Products | 3+0 |
| DM-723 | Advances in Probiotics and Functional Foods | 3+0 |
| DM-729 | Credit seminar | 1+0 |
Semester-wise breakup of courses allotted to M.Tech. / M.Sc. (Dairying), (2019-2020) 20.7.19
| - | Course No. | Course Title | Credits |
|---|---|---|---|
| I SEM | |||
| Major | DM-611 | Microbial Morphology and Taxonomy | 2+1 |
| DM-612 | Microbial Physiology | 2+1 | |
| DM-613 | Microbiology of Fluid Milk and Dairy Products | 2+1 | |
| DM-615 | Microbiology of Processed Dairy Foods | 2+1 | |
| Minor | DC-614 | Food Chemistry | 2+1 |
| Supporting | AB-611 | Basic Biochemistry | 2+1 |
| Non credit | HI- 100 | Hindi | 3+0 |
| PE -611 | Physical Education | 0+1 | |
| GS-633 | Intellectual Property and Its Management in Agriculture | 1+0 | |
| GS-635 | Disaster Management | 1+0 | |
| II SEM | |||
| Major | DM-621 | Starter Cultures and Fermented Dairy Products | 2+1 |
| DM-622 | Microbial Genetics | 2+1 | |
| DM-623 | Microbiological Quality Assurance | 2+1 | |
| DM-624 | Probiotics for Health Foods | 2+1 | |
| DM-625 | Research Techniques in Dairy Microbiology | 2+1 | |
| DM-626 | Microbial Fermentation Technology | 2+1 | |
| Minor | DC-623 | Chemical Quality Assurance | 2+1 |
| Supporting | ES-627 | Statistics for Industrial Applications | 3+1 |
| Non credit | GS-631 | Library and Information Services | 0+1 |
| TW-611 | Technical Writing | 1+1 | |
| - | PE-611 | Physical Education | 0+1 |
| Credit Seminar | DM-629 | Credit Seminar | 1+0 |
Semester-wise breakup of courses allotted to Ph.D. Dairy Microbiology
(2019-2020) 20.7.19
| - | Course No. | Course Title | Credits |
|---|---|---|---|
| I SEM | |||
| Major | DM- 711 | Microbial Diversity and Physiology | 3+0 |
| DM- 712 | Advances in Microbial Genetics | 3+0 | |
| Minor | AB-613 | Biochemical Techniques | 3+1 |
| AB -614 | Food and Nutritional Biochemistry | 3+0 | |
| - | AB-713 | Functional Genomics, Proteomics and Metabolomics | 2+0 |
| Supporting | FS-712 | Biotechnological interventions in Food Safety & Quality Assurance | 3+0 |
| Non credit | GS -633 | Intellectual Property and its Management in Agriculture | 1+0 |
| GS- 635 | Disaster Management | 1+0 | |
| HI -100 | Hindi | 3+0 | |
| PE-611 | Physical Education | 0+1 | |
| Credit Seminar | DM-719 | Credit seminar | 1+0 |
| II SEM | |||
| Major | DM -721 | Advances in Dairy and Food Microbiology | 3+0 |
| DM -722 | Advances in Food Safety of Dairy Products | 3+0 | |
| DM -723 | Advances in Probiotics and Functional Foods | 3+0 | |
| Minor | AB-623 | Immunochemistry | 2+1 |
| Supporting | CS-621 | Software Package for Statistical Computing | 2+1 |
| - | DC- 624 | Research Techniques | 2+1 |
| Non credit | GS -631 | Library and Information Service | 0+1 |
| TW-711 | Technical Writing | 0+1 | |
| PE -621 | Physical Education | 0+1 | |
| Credit Seminar | DM-729 | Credit Seminar | 1+0 |
Semester-wise breakup of Pre-requisite courses to be allotted to M.Sc./M.Tech Dairy Microbiology
Students with three years Bachelor’s degree
(2019-20) 20.7.19
| Course No. | Pre-Requisite Courses | Credits |
|---|---|---|
| I SEM | ||
| DM-111 | Fundamentals of Microbiology | 2+1 |
| DC-111 | Physical Chemistry of Milk | 2+1 |
| MP-111 | Milk Production Management and Dairy Development | 2+1 |
| DM-311 | Quality and Safety Monitoring in Dairy Industry | 2+1 |
| DT-312 | Packaging of Dairy Products | 2+1 |
| ES-311 | Industrial Statistics | 2+1 |
| II SEM | ||
| DM-121 | Microbiology of Fluid Milk | 2+1 |
| DC-122 | Chemistry of Milk | 2+1 |
| DT-121 | Market Milk | 3+1 |
| DM-221 | Starter Cultures and Fermented Milk Products | 2+1 |
| DM-222 | Microbiology of Dairy Products | 2+1 |
| DM-321 | Food and Industrial Microbiology | 2+1 |
Semester-wise breakup of Pre-requisite courses to be allotted to Ph.D. Dairy Microbiology students
admitted with Basic Science/ Non-Dairying background
(2019-20) 20.7.19
| Course No. | Course Title | Credits |
|---|---|---|
| I SEM | ||
| DM-613 | Microbiology of Fluid Milk and Dairy Products | 2+1 |
| DM-615 | Microbiology of Processed Dairy Foods | 2+1 |
| DC-611 | Physico-chemical Aspects of Milk Constituents | 2+1 |
| DC-612 | Milk Carbohydrates, Minerals and Water Soluble Vitamins | 2+1 |
| FT-615 | Technology of Milk and Milk Products | 2+1 |
| AB-611 | Basic Biochemistry | 3+1 |
| II SEM | ||
| DM-621 | Starter Culture and Fermented Dairy Foods | 2+1 |
| DM-623 | Microbiological Quality Assurance | 2+1 |
| DM-625 | Research Techniques in Dairy Microbiology | 2+1 |
| DM-626 | Microbial Fermentation Technology | 2+1 |
| DC-622 | Chemistry of Milk Products | 2+1 |
| DT-624 | Functional Foods and New Product Development | 3+1 |
Courses Offerred for Food Safety and Quality Assurance (FSQA)
(2019-2020)
- Tech Food Safety and Quality Assurance (FSQA)
| Course No. | Course Title | Credits |
|---|---|---|
| I SEM | ||
| FS-611 | Basic Concepts of Quality Assurance and Food Safety System | 2+1 |
| FS-612 | Risk Analysis Concept and Regulatory Standards for Foods | 2+1 |
| FS-613/DM- 613 | Microbiology of Fluid Milk and Dairy Products | 2+1 |
| FS-614 | Food Microbiology | 2+1 |
| FS-615/DC-614 | Food Chemistry | 2+1 |
| FS-619 | Credit seminar | 1+0 |
| II SEM | ||
| FS-621/DM-623 | Microbiological Quality Assurance | 2+1 |
| FS-622/DC-622 | Chemistry of Milk Products | 2+1 |
| FS-623/DC-623 | Chemical Quality Assurance | 2+1 |
| FS-624/DC- 624 | Research Techniques | 2+1 |
| FS-625/DM-625 | Research Techniques in Dairy Microbiology | 2+1 |
| FS-626/DM -621 | Starter Cultures and Fermented Dairy Products | 2+1 |
- Ph.D Food Safety and Quality Assurance (FSQA)
| Course No. | Course Title | Credits |
|---|---|---|
| I SEM | ||
| FS-711 / DC-713 | Advances in Chemistry of Functional Dairy Foods and Nutraceuticals | 3+0 |
| FS-712 | Biotechnological Interventions in Food Safety & Quality Assurance | 3+0 |
| FS-719 | Credit seminar | 1+0 |
| II SEM | ||
| FS-721 / DC-721 | Advances in Chemistry of Milk Processing | 3+0 |
| FS -722/ DC-722 | Advances in Analytical Techniques in Dairy Chemistry | 3+0 |
| FS-723/ DM-722 | Advances in Microbial Safety of Dairy Foods | 3+0 |
| FS-729 | Credit seminar | 1+0 |
Semester-wise breakup of courses allotted to M.Tech. / M.Sc. (Dairying), FSQA 20.7.19
(2019-2020)
| - | Course No. | Course Title | Credits |
|---|---|---|---|
| I SEM | |||
| Major | FS-611 | Basic Concepts of Quality Assurance and Food Safety sytem | 2+1 |
| FS-612 | Risk Analysis Concept and Regulatory Standards for Foods | 2+1 | |
| FS-613/ DM-613 | Microbiology of Fluid Milk and Dairy Products | 2+1 | |
| FS-614/FN-613 | Food Microbiology | 2+1 | |
| FS-615/DC- 614 | Food Chemistry | 2+1 | |
| Minor | FT-615 | Technology of Milk and Milk Products | 2+1 |
| FT-611 | Principles of Food Processing | 3+1 | |
| Credit seminar | FS-619 | Credit seminar | 1+0 |
| Supporting | - | - | - |
| Non credit | GS-633 | Intellectual Property and Its Management in Agriculture | 1+0 |
| GS-635 | Disaster Management | 1+0 | |
| HI- 100 | Hindi | 3+0 | |
| PE -611 | Physical Education | 0+1 | |
| II SEM | |||
| Major | FS-621/DM-623 | Microbiological Quality Assurance | 2+1 |
| FS-622/DC-622 | Chemistry of Milk Products | 2+1 | |
| FS-623/DC-623 | Chemical Quality Assurance | 2+1 | |
| FS-624/DC-624 | Research Techniques | 1+2 | |
| - | FS-625/DM-625 | Research Techniques in Dairy Microbiology | 2+1 |
| - | FS-626/DM-621 | Starter Cultures and Fermented Dairy Products | 2+1 |
| Minor | FT-623 | Technology of Fruits and Vegetables | 2+1 |
| - | FT-624 | Technology of Meat, Poultry and Fish | 2+1 |
| - | FT-625 | Technology of Cereals, Pulses and Oil Seeds | 2+1 |
| Supporting | ES-627 | Statistics for Industrial Applications | 3+1 |
| Credit seminar | FS-629 | Credit seminar | 1+0 |
| Non credit | GS -631 | Library and Information Service | 0+1 |
| TW-611 | Technical Writing | 1+1 | |
| - | PE-621 | Physical Education | 0+1 |
Semester-wise breakup of courses allotted to Ph.D (Dairying), FSQA students
(2019-2020) 20.7.19
| - | Course No. | Course Title | Credits |
|---|---|---|---|
| I SEM | |||
| Major | FS-711 / DC-713 | Advances in Chemistry of Functional Dairy Foods and Nutraceuticals | 3+0 |
| FS-712 | Biotechnological interventions in Food Safety & Quality Assurance | 3+0 | |
| Minor | FT-611 | Principles of Food Processing | 3+1 |
| FT-615 | Technology of Milk and Milk Products | 2+1 | |
| Supporting | - | - | - |
| Non credit | GS-633 | Intellectual Property and Its Management in Agriculture | 1+0 |
| GS-635 | Disaster Management | 1+0 | |
| HI- 100 | Hindi | 3+0 | |
| PE -611 | Physical Education | 0+1 | |
| Credit seminar | FS-719 | Credit seminar | 1+0 |
| II SEM | |||
| Major | FS-721 /DC- 721 | Advances in Chemistry of Milk Processing | 3+0 |
| FS -722 /DC-722 | Advances in Analytical Techniques in Dairy Chemistry | 3+0 | |
| FS-723/DM- 722 | Advances in Microbial Safety of Dairy Foods | 3+0 | |
| Minor | FT -621 | Advanced Food Engineering | 2+1 |
| FT-622 /DT-622 | Advanced Dairy and Food Packaging | 2+1 | |
| Supporting | ES-627 | Statistics for Industrial Applications | 3+1 |
| CS-621 | Software Package for Statistical Computing | 2+1 | |
| Non credit | GS -631 | Library and Information Service | 0+1 |
| TW-711 | Technical Writing | 1+1 | |
| PE -621 | Physical Education | 0+1 | |
| Credit seminar | FS-729 | Credit seminar | 1+0 |
Semester-wise breakup of Pre-requisite courses to be allotted to M.Sc./M.Tech Food Safety and Quality Assurance
Students with three years Bachelor’s degree
(2019-2020) 20.7.19
| Course No. | Pre-Requisite Courses | Credits |
|---|---|---|
| I SEM | ||
| DM-111 | Fundamentals of Microbiology | 2+1 |
| DC-111 | Physical Chemistry of Milk | 2+1 |
| MP-111 | Milk Production Management and Dairy Development | 2+1 |
| DM-311 | Quality and Safety Monitoring in Dairy Industry | 2+1 |
| DC-311 | Chemical Quality Assurance | 2+1 |
| ES-311 | Industrial Statistics | 2+1 |
| DT-312 | Packaging Of Dairy Products | 2+1 |
| II SEM | ||
| DM-121 | Microbiology of Fluid Milk | 2+1 |
| DC-122 | Chemistry of Milk | 2+1 |
| DT-121 | Market Milk | 3+1 |
| DM-221 | Starter Cultures and Fermented Milk Products | 2+1 |
| DM-222 | Microbiology of Dairy Products | 2+1 |
| DM-321 | Food and Industrial Microbiology | 2+1 |
Semester-wise breakup of pre-requisite courses to be allotted to Ph.D. FSQA students admitted with
basic science/ Non-Dairying background
(2019-20) 20.7.19
| Course No. | Course Title | Credits |
|---|---|---|
| I SEM | ||
| FS-611 | Basic Concepts of Quality Assurance and Food Safety System | 2+1 |
| FS-612 | Risk Analysis Concept and Regulatory Standards for Foods | 2+1 |
| FS-614/ FT-613 | Food Microbiology | 2+1 |
| DC-614 | Food Chemistry | 2+1 |
| DM -613 | Microbiology of Fluid Milk and Dairy Products | 2+1 |
| II SEM | ||
| DM- 621 | Starter Cultures and Fermented Dairy Foods | 2+1 |
| DM-623 | Microbiological Quality Assurance | 2+1 |
| DM-625 | Research Techniques in Dairy Microbiology | 2+1 |
| DC-622 | Chemistry of Milk Products | 2+1 |
| DC-623 | Chemical Quality Assurance | 2+1 |
| ES-627 | Statistics for Industrial Applications | 3+1 |
DM 711: Microbial Diversity and Physiology
Objective
To understand the advances in microbial diversity and physiology for its interface with all other branches of microbiology.
Theory
Unit I
Bacterial growth: cell division, phases of bacterial growth, factors affecting microbial growth, kinetics of growth, continuous culture system, diauxic and synchronous growth, advances in growth measurement.
Unit II
Prokaryotic cellular structures, biosynthesis of bacterial cell-wall, enterobacterial common antigens, role of membrane in regulation of cell-wall and DNA synthesis, physiology and genetic aspects of sporulation.
Unit III
Autotrophy, nutritional classification, chemolithotrophic electron transport systems: hydrogen oxidizing bacteria, sulfate reducing hydrogen bacteria, methanogenic hydrogen utilization, nitrifying bacteria, sulfur oxidizing bacteria, carbon monoxide oxidizing organisms, economic importance of autotrophs.
Unit IV
Membrane transport systems: types of transport: ion transport, iron transport, simple diffusion, facilitated diffusion, active transport, mechanosensitive channel, ATP binding cassette transporter family, chemiosmotic driven transport, phosphotransferase system.
Unit V
Environmental selection and microbial stress response: osmotic stress, aerobic to anaerobic transitions, oxidative stress, pH stress and acid tolerance, thermal stress and nutritional stress, extremophiles.
Suggested Readings
- Cowan, M. K. 2012. Microbiology: A Systems Approach, 3rd Edn. The McGraw−Hill Companies, New York, USA.
- Madigan, M. T., Martinko, J.M. and Parker, J. 2012. Brock Biology of Microorganisms, 13th Edn., Prentice Hall, London, U.K. edition, Prentice Hall, London, U.K.
- Moat AG, Foster JW & Spector MP. 2004. Microbial Physiology. 4th Ed. John Wiley & Sons, USA
- Ogunseitan, O. 2005. Microbial Diversity: Form and Function in Prokaryotes Blackwell Publishing, Malden, USA.
- Xie et al.2011. Bacterial flagellum as a propeller and as a rudder for efficient chemotaxis. PNAS 108 (6): 2246-51.
DM 712 Advances in Microbial Genetics
Objective
To familiarize the students with basic concepts of Microbial Genetics and impart them knowledge in advancements of Microbial Genetics and Genetic Engineering
Theory
Unit I
Essentials of Microbial Genetics – Introduction, Historical perspective and principles; Nucleic Acids: Structure and Function of DNA and RNA; DNA Replication –Recent models; Genetic Code
Unit II
Mutations – Spontaneous and Induced mutations; Types of mutations; Mutagenic agents – Physical and Chemical; Molecular basis of Mutagenesis; DNA Damage and Repair – Molecular Mechanisms; Site Directed Mutagenesis – Methods of directed mutagenesis, mechanism and applications
Unit III
Gene Expression – Transcription , Translation, Regulation of Gene Expression Operon models, Regulation of Gene Expression Operon models (Lac), Regulation of Gene Expression Operon models (Gal), Regulation of Gene Expression Operon models ( Trp)
Unit IV
Plasmids – Structure and replication; Transposable elements – IS and Tn elements; molecular mechanism of transposition; Genetic Recombination: Transformation, Transduction and Conjugation; Recombination methods as a tool for Gene mapping
Unit V
Genetic Engineering/ rDNA – Principles of recombinant DNA technology; Restriction Enzymes – Types, Mode of action and application as a tool for gene manipulation, Vectors – Cloning and expression vectors; PCR cloning, Microarray technology, Gene Silencing and Gene knock out
Suggested Reading
- Dyson MR & Durocher Y. (2007). Expression Systems. Scion Publ.
- Hartl D, Jones L & Elizabeth W. (2000). Genetic Analysis of Genes and Genomes. Jones Bartkett Publ.
- Keuzer H & Massey A. (2001). Recombinant DNA and Biotechnology. 2nd Ed… ASM Press.
- Streips UN & Yasbin RE. (2002). Modern Microbial Genetics. 2nd Ed. John Wiley & Sons.
- Synder L & Champness W. (2003). Molecular Genetics of Bacteria. 2nd Ed. ASM Publ.
- James D. Watson, A. Baker Tania, P. Bell Stephen, Gann Alexander, Levine Michael, Losick Richard (2017). Molecular Biology of the Gene. Pearson.
DM-721 Advances in Dairy and Food Microbiology
Objective
To study and understand the current trends and recent concepts related microbiology of dairy and other foods products.
Theory
Unit I
Lactic acid bacteria and food fermentations important metabolic pathways of microorganisms; current status of metabolism of starters cultures; current trends in lactic starter for industrial applications, novel starter preservation techniques.
Unit II
Modern concepts in cheese ripening; Bacteriology and starter rotations, improving starter cultures for food fermentation by genetic manipulation, recombination technology.
Unit III
Bacteriocins of lactic acid bacteria, structure, function transport and mode of action; Application of bacteriocins in foods Biopreservation.
Unit IV
Current trends in food safety; newly emerging pathogens; Ecology and survival strategy of pathogens in foods. Novel technology in control of food based pathogens. Concepts in food toxicology; food borne toxins, current concepts in food quality and safety management
Suggested Readings
- Osman Erkmen, T. FarukBozoglu (2016) Food Microbiology: Principles into Practice, 2 Volume Set. Wiley Publishing
- Hae-Soo Kwak (2015) Nano- and Microencapsulation for Foods.Wiley Publishing
- Suvendu Bhattacharya (2014) Conventional and Advanced Food Processing Technologies. Wiley Publishing.
- Debasis Bagchi, Francis C. Lau, Dilip K. Ghosh (2010). Biotechnology in Functional Foods and Nutraceuticals (1st Edition, 2010), published by CRC Press, USA.
- Barbaros Ozer, Gülsün Akdemir-Evrendilek (2014) Dairy Microbiology and Biochemistry: Recent Developments. CRC Press
DM-722 Advances in Food Safety of Dairy Foods
Objectives
To impart current knowledge pertaining to microbial risk assessment of dairy pathogens and their safety concern in dairy foods.
Theory
Unit I
Milk borne diseases, epidemiology and surveillance in dairy products: Current trends, incidence and surveillance of milk borne diseases; Changing patterns in epidemiology, agricultural and food manufacturing practices, transmission and susceptibility.
Unit II
General mechanism of microbial pathogenesis: Food borne infection by colonization and adhesion factors like pilli or fimbriae, adhesion proteins, biofilm formation; Invasion and intracellular residence; Phagocytosis, invasion mediated induced phagocytosis; Iron acquisition; Motility and chemotaxis, invasion of immune system; Intoxication; Toxi-infection, structure and function of exotoxins and endotoxin; Genetic regulation and secretary system for virulence factors.
Unit III
Unit IV
Microbiological risk profile of dairy foods: Hazard identification and characterization in dairy products; Evidence of antimicrobial resistant bacteria in milk and milk products; Risk factors affecting microbial safety of raw and processed dairy foods; Exposer assessment and risk characterization; Attribution of food-borne illness to dairy products; Risk management issues and control strategies for dairy products.
Suggested Readings
- Bhunia AK 2008 Foodborne Microbial Pathogens: Mechanisms and Pathogenesis. Purdue University West Lafayette, IN, USA.
- Antimicrobial Resistance in Bacteria from Livestock and Companion Animals (2018). Stefan Schwarz (Professor of veterinary medicine), Lina Maria Cavaco, Jianzhong Shen, Frank M. Aarestrup and published by ASM Press.
- Quantitative Microbial Risk Assessment. Charles N. Haas, Joan B. Rose, Charles P. Gerba John Wiley & Sons, 09-Jun-2014 – Technology & Engineering.
- Indira T. Kudva, Tracy Nicholson (2016). Virulence Mechanisms of Bacterial Pathogens. ASM Press.
- D. Scott McVey, Melissa Kennedy, M. M. Chengappa (2013). Veterinary Microbiology John Wiley & Sons.
- Charles Yoe (2016). Principles of Risk Analysis: Decision Making Under Uncertainty. Publisher – Technology & Engineering
- William HS and Michael PD 2009 Compendium of the Microbiological spoilage of food and Beverage. Springer Science. Heidelberg, London.
DM-723 Advances in Probiotics and Functional Foods
Objective:
To familiarize the students with the concept of probiotics, prebiotics and functional foods and their application in human health
Theory
Unit I
Probiotics: Introduction and history, Characteristics of Probiotics for selection, Stability during storage and passage to gastrointestinal tract
Unit II
Probiotic mode of action and disease control: Homeostasis of disturbed commensal microbial flora in the gut, pathogen exclusion, production of antimicrobial substances, modulation of immune system, alteration of intestinal bacterial metabolite action, alteration of microecology of healthy humans and patients.
Unit III
Prebiotics, Synbiotics and Postbiotics: Concept and definitions, criteria, types and sources of prebiotics, prebiotics and gut microbiota
Unit IV
Functional foods: Nutraceuticals, Medical/health foods, functional foods ingredients and their role in human health and nutrition
Unit V
Dairy based functional foods: Dahi, lassi, yoghurt, kefir, cheese, kefir, koumiss, Yakult, fermented whey drinks, and dairy based cereal foods, Indigenous fermented dairy foods fortified with fruit pulp/ herbs and their bioactive components
Unit VI
Cereals, soya, plant based and other functional foods: Miso, Kimchi, Saurerkraut, Sake ,Ogi, Gundruk, Natto, Doenjang, Tempheh, Douchi, Cheonggukjang, Soy based fermented foods: yoghurt, dahi, beverages and cheese, fermented meat products.
Unit VII
Microbial production of Bioactive compounds: Bacteriocins, Bioactive peptides, Conjugated Linoleic Acids, gamma-Aminobutyric acid, Vitamins (Folate, Riboflavin, Vitamin B12), Low calorie sugars (Xylitol, Sorbitol, Mannitol, Trehalose), Micronutrients (Selenium, Zinc).
Unit VIII
Health benefits of probiotics/functional foods: Gastrointestinal disorders, Metabolic syndrome including cardiovascular diseases, diabetes and obesity, Brain health, Immunological disorders, Cancer, Health and well being in Ageing, alcoholic and non alcoholic liver disease, Reproductive and Hormonal disorders, Mental health.
Unit IX
Scientific Assessment of probiotics/functional foods: Role of Biomarkers, Application of Proteomics, Metabolomics, Nutrigenetics and Nutrigenomics Nutrigenomics in establishing scientific evidence of functional foods for imparting health benefits
Unit X
Regulations and Future prospects of probiotics and functional foods: Legal status of probiotics, safety and regulatory aspects and Future prospects.
Unit XI
Next generation probiotics (Designer probiotics): Robust probiotic strains with stress survival systems, enhanced adhesion ability and surface markers etc. and for mucosal delivery of vaccines
Suggested Readings
- GB Huffnagle. (2008). The Probiotics Revolution: The Definitive Guide to Safe, Natural Health Solutions Using Probiotic and Prebiotic Foods and Supplements. Bantam, USA.
- Robert Keith Wallace (Author), Samantha Wallace (2017). Gut Crisis: How Diet, Probiotics, and Friendly Bacteria Help You Lose Weight and Heal Your Body and Mind. Dharma Publication, Fairfield, USA.
- Hae-Soo Kwak (2015) Nano- and Microencapsulation for Foods. Wiley Publishing
- Edward R. (Ted) Farnworth (2008) Handbook of Fermented Functional Foods. CRC Press
- Fermented Foods in Health and Disease Prevention. (2016) Edited by Juana Frias, Cristina Martinez-Villaluenga and Elena Peñas. Elsevier Inc.
DM-611 Microbial Morphology and Taxonomy
Objective
To educate the taxonomy and morphological features of the various microorganisms, viz., bacteria, fungi and viruses.
Theory
Unit I
Evolution of life on earth, history and diversity of microorganisms
Unit II
Principles of classification and taxonomy of Eubacteria (Bacteria and Archaea): Major characteristics used in taxonomy: Cultural, Morphological, Biochemical, Physiological,Genetic and Molecular; Numerical Taxonomy (Taxometrics) and Chemotaxonomy. Assessing Microbial Phylogeny: Chronometers. Phylogenetic trees, r-RNA, DNA and proteins as indicators of phylogeny.
Unit III
Cell ultra-structure (prokaryotes and eukaryotes) cell-wall: structure, chemical composition, synthesis and inhibition, cell membrane, cytoplasmic inclusions, cytoskeleton, cell appendages, capsule, flagella, pili, sporulation structure of endospore, composition and function of spore constituents, induction and germination
Unit IV
Fungi: Distribution, Importance and recent Classification, Study of Yeasts and Moulds in Dairy Foods
Unit V
History, Development and Scope of Virology. Classification and Nomenclature, characteristics of Viruses (Acellular Organization and Viral Genome), Viral Reproduction, Brief account of Viroids and Prions.
Practicals
- Staining: Simple and differential staining; Gram’s staining, spore staining, acid-fast staining, cell wall staining, flagella staining, nucleoids staining, capsule staining, and inclusion/storage bodies staining
- Preparation of bacterial protoplasts and spheroplasts
- Measuring dimensions of microorganisms (bacteria) using micrometry
- Morphology of fungi
- Detection and enumeration of bacteriophages in Cheese whey
- Application of computer software in bacterial identification
- Electron microscopic observation of Ultra-structure of Microbial Cell(Demonstration)
Suggested Readings
- Cowan, M. K. 2012. Microbiology: A Systems Approach, 3rd Edition. The McGraw−Hill Companies, New York, USA.
- Holt, J.G., Krieg, N.R., Sneath, P.H.A., Staley, J.T. and Williams, S.T. 1997. Bergey’s Manual of Determinative Bacteriology (9th edition). Williams and Wilkins, Baltimore, Maryland, USA.
- Krejer van-Rij, NJW 1998, The yeasts: A taxonomic study, 4th edn, Elsevier Science Publishers, Amsterdam, The Netherlands.
- Madigan, M. T., Martinko, J.M. and Parker, J. 2015. Brock Biology of Microorganisms.14th edition, Prentice Hall, London, U.K.
- Prescott, LM, Harley, JP & Klein, DA 2002, Microbiology, 5th edn, McGraw Hill, New York, USA.
- Tolaro, K.P. 2011. Foundations in Microbiology, 8th Edn., The McGraw−Hill Companies, New York, USA.
DM-612 Microbial Physiology
Objective
To familiarize the student with the various aspects of growth and energy generating activities of bacteria for the betterment of human life.
Theory
Unit I
Bacterial growth: growth phases and kinetics, synchronous, continuous, and associative growth; factors affecting bacterial growth; growth measurement.
Unit II
Effect of environment on the growth of bacteria: temperature, air, osmotic pressure, pH, hydrostatic pressure, surface tension, metals, electromagnetic and other waves, sonics, various chemicals; their application in dairy industry; mechanisms of action of antimicrobials.
Unit III
Bacterial nutrition; nutrient media; nutritional groups of bacteria; role of growth factors; active and passive transport.
Unit IV
Electron transport chain: Electron transport chain; fermentation, respiration and photosynthesis
Practicals
- Measurement of bacterial growth by direct methods (cell number, SPC, DMC) and indirect methods (turbidometric methods, MPN, cell mass).
- Preparation of growth curve; determination of generation time.
- Determination of cell activity; carbohydrate fermentation; acid production/pH alteration; starch, lipid, casein and gelatin hydrolysis.
- Effect of different factors viz., physical (temperature, pH, osmotic pressure, surface tension), chemical (dyes, antibiotics, phenol) and nutritional (amino acid supplements, vitamin supplements, protein hydrolysates, casamino acids) on bacterial growth.
Suggested Reading
- Moat AG, Foster JW & Spector MP. 2002. Microbial Physiology. 4th Wiley-Liss.
- RK Poole. 2006. Advances in Microbial Physiology. Apple Academic Press (CRC Press), USA
- Gerald Robert Seaman and Jody De Mary. 2012. Experiments in Microbial Physiology and Biochemistry. Literary Licensing, LLC, USA
- AH Rose. 2009. Chemical Microbiology: An Introduction to Microbial Physiology. Plenum Pub. Corp.
- Prescott’s Microbiology (10thEdition, 2017) By Joanne Willey, Linda Sherwood and Christopher J. Woolverton
- Microbial Physiology (2017) by Dean Watson
DM-613 Microbiology of Fluid Milk and Dairy Products
Objective
To impart current knowledge of basic and applied microbiological aspects of fluid milks and dairy products for improved quality and food safety.
Theory
Unit I
Common microbes in milk and their significance. Microflora of mastitis milk and its importance in dairy industry. Sources of microbial contamination of raw milk and their relative importance in influencing quality of milk during production, collection, transportation and storage. Clean milk production and antimicrobial systems in raw milk. Microbial changes in raw milk during long storage. Microbiological grading of raw milk.
Unit II
Microbiological aspects of processing techniques like: bactofugation, thermization, pasteurization, sterilization, boiling, UHT, non thermal processes (pulse field) and membrane filtration of milk. Role of psychrotrophic, mesophillic, thermophilic and thermoduric bacteria in spoilage of processed milks, their sources and prevention. Heat induced damage in bacteria and role of resuscitation in recovery of injured microbial cells. Microbiological standards (BIS/ PFA) of heat treated fluid milks.
Unit III
Microbiological quality of dairy products; fat rich (cream and butter), frozen (ice cream), concentrated (evaporated and condensed milk), dried milks (roller and spray dried), infant dairy foods and legal standards. Factors affecting microbial quality of these products during processing, storage and distribution. Microbiological defects associated with these products and their control.
Unit IV
Microbiological quality of traditional dairy products; heat desiccated (khoa, burfi, peda, kheer), acid coagulated (paneer, chhana, rasgulla), fermented (lassi, srikhand) and frozen (kulfi). Sources of microbial contaminants and their role in spoilage. Importance of personnel and environmental hygiene on quality of traditional milk products. Microbiological standards for indigenous dairy foods.
Unit V
Definition of food poisonings, food infections and toxi-infections, pathogens associated with fluid milks, dairy products and their public health significance. Sources of pathogens and their prevention. Importance of biofilms, their role in transmission of pathogens in dairy products and preventive strategies.
Practicals
- Grading of raw milk based on SPC, coliform and dye reduction tests.
- Effect of different storage temperatures on microbiological quality of fluid milk
- Tests for mastitic milk and brucellosis
- Microbiological quality evaluation of cream and butter for yeasts & molds, lipolytic and proteolytic bacteria.
- Detection of Enterobactersakazakii in infant dairy foods.
- Microbial evaluation of Burfi and Peda for SPC, yeast and mould counts.
- Detection of Bacillus cereus, Salmonella,Shigellaand coagulase positive staphylococci in milk powder.
- Evaluation of ice cream for coliforms and coli
- Microbiological quality of Paneer
- Enumeration of aerobic and anaerobic spores in condensed and sterilized milk.
- Line testing for determining the source of contamination of dairy products.
Suggested Readings
- Osei. 2017. Handbook of Dairy Microbiology. AGri-Horti Press
- Palmiro Poltronieri (Editor) 2017. Microbiology in Dairy Processing: Challenges and Opportunities John Wiley & Sons Inc
- Barbaros Eozer. 2014. Dairy Microbiology and Biochemistry: Recent Developments. CRC Press, USA
- B A Law. 2012. Microbiology and Biochemistry of Cheese and Fermented Milks. Springer Publisher.
- Rhea Fernandes (Editor). 2009. Microbiology Handbook: Dairy Products. RSC Publishing
- Melanie Quin. 1989. Applied microbiology in the Dairy Industry. Hobsons Publishing PLC
DM-614 Environmental Microbiology
Objective
To understand the fundamentals of environmental microbiology and role of microorganisms in combating the organic pollutants in the environment.
Theory
Unit I
Environmental microbiology; soil as a microbial environment, microbes in surface soils and subsurface environments; Aero-microbiology; airborne pathogens, toxins, aerosols, nature and control of bio-aerosols, aero-microbiological pathway, microbial survival in air, extramural and intramural aero-microbiology; Aquatic environments and microbial habitats.
Unit II
Extreme environments, low and high temperature, desiccation, UV stress, pH and environment based on chemoautotrophy; Environmental sample collection; strategies, methods, processing and storage of soil and water sample for the detection of bacteria and phages; Mechanism for the collection of air samples; Cultural methods for isolation and enumeration of bacteria and fungi.
Unit III
Biogeochemical cycles; carbon cycles (fixation, energy flow and respiration), nitrogen cycle (fixation, ammonia assimilation, nitrification and nitrate reduction) sulfur cycle (assimilatory sulphate reduction, sulphur mineralization, oxidation and reduction), iron cycle (in soil, sediments and marine environment); Microbially influenced metal corrosion, acid mine drainage, metal recovery and desulfurization.
Unit IV
Microbes and organic pollutants; environmental laws and issues concerning release of genetically engineered microbes, biodegradation process, contaminant structure and toxicity (genetic potential and bioavailability), factors affecting biodegradation (redox conditions, organic matter composition, nitrogen etc); biodegradation of organic pollutants, bioremediation (addition of oxygen, nutrient, surfactant, microbes etc).
Unit V
Environmentally transmitted microbial pathogens (Salmonella, E. coli, Campylobacter Yersinia etc) and viruses (enteric and respiratory), Indicator microorganisms (concept, total and fecal coliforms, fecal streptococci, bacteriophage etc). Solid wastes management and waste water treatment and bio-solids reuse in food and dairy industry.
Practicals
- Determination of composite micro-flora (i.e. total bacteria, coliforms, yeasts and moulds etc) of selected environmental samples from soil.
- Estimation of micro-flora (i.e. total bacteria, coliforms, yeasts and moulds etc) of selected environmental samples from water.
- Study of micro-flora (i.e. total bacteria, yeasts and moulds etc) of selected environmental samples from air.
- Isolation of dye degrading bacteria from the selected environmental samples.
- Enrichment and isolation of plastic degrading microorganisms from environmental samples.
- Isolation of industrial effluent degrading microorganisms from the environmental samples.
- Characterization of bio-indicators from the environmental samples (total coliforms, faecal enterococci, and heterotrophic plate counts; total coliforms through MPN method; bacteriophage isolation etc).
- Determination of biochemical oxygen demand in waste water sample.
- Visit to a sewage or an industrial effluent treatment plant.
DM-615 Microbiology of Processed Dairy Foods
Objective
To understand the microbiology of processed foods, significance of different food microorganisms, their control and other related aspects.
Theory
Unit I:
Introduction to microbes in foods, history & development of food microbiology, microorganisms important in foods, microbial ecology of processed foods and food ecosystem, factors influencing microbial growth in foods: intrinsic factors and extrinsic factors.
Unit II:
High temperature food preservation, factors affecting heat resistance in microorganisms, thermal destruction of microorganisms, low temperature food preservation, food preservation by irradiation, food preservation by drying and fermentation, modern processing techniques – ohmic heating, high pressure processing, infra-red heating, cold plasma, pulsed electric field, ultra sound etc., bio preservation of foods – concepts: metabolites of lactic acid bacteria; bacteriocins, Antifungal substances etc., protective cultures and other antimicrobials (herbs, spices and other natural antimicrobial compounds), Nanoscience in food preservation; microencapsulation.
Unit III:
Microbial stress response in the food environment; stress adaptation, sublethal stress & injury, antibiotic resistance in food bacteria, predictive modelling for food spoilage, industrial strategies for ensuring safe foods, HACCP; GMP, GHP
Unit IV:
Antimicrobial packaging; concepts and development, modified atmosphere packaging (MAP), intermediate moisture foods (IMF), and hurdle technology in processed foods.
Unit V:
New prospects and problems in processed dairy foods. Genetically modified foods.
Practicals
- D and Z-value calculation of common food pathogens.
- Production of antimicrobial substances – bacteriocins.
- Production of antifungal substances.
- Application of bacteriocins for bio preservation of foods.
- Application of hurdle concepts for enhanced shelf stability of processed foods.
- Induction of bacterial cell injury and recovery of injured cells.
- Antibiotic resistance of food pathogens.
- Shelf life enhancement using antimicrobial packaging.
Suggested Readings
- Ray B. 2003. Fundamental Food Microbiology. CRC Press.
- Ramesh C. Ray, Montet Didier. Microorganisms and Fermentation of Traditional Foods. CRC Press, U.S.A.
- Neusely da Silva, Marta Hirotomi Taniwaki, Valéria Christina Junqueira, Neliane Silveira, Maristela da Silva do Nascimento, Renato Abeilar Romeiro Gomes. 2012. Microbiological Examination Methods of Food and Water: A Laboratory Manual. CRC Press, USA.
- Photis Papademas. 2014. Dairy Microbiology: A Practical Approach. CRC Press.
- Osman Erkmen, T. FarukBozoglu (2016) Food Microbiology: Principles into Practice, 2 Volume Set. Wiley Publishing
- Barbaros Ozer, Gülsün Akdemir-Evrendilek (2014) Dairy Microbiology and Biochemistry: Recent Developments. CRC Press
DM-621 Starter Cultures and Fermented Dairy Products
Objective
To familiarize the students with the starter organisms, their metabolism and genetics; different types of starters, propagation, preservation and applications of starters.
Theory
Unit I
Taxonomy and characteristics of starter cultures: Taxonomy and natural habitat of starter organisms; characteristics of starter organisms: Lactococcus, Leuconostoc, Streptococcus, Pediococcus, Lactobacillus, Bifdobacterium Enterococcus, Propionibacterium, Brevibacterium, yeasts and molds. Desirable properties of lactic acid bacteria for different fermented milk products.
Unit II
Metabolism and genetics of starter cultures: Carbohydrate, citrate and protein metabolism: lactose, galactose and glucose metabolism- transport of sugars across the cell boundaries, homolactic and heterolactic fermentation, other pathways of sugar metabolism, citrate transport and metabolism formation of flavouring agents from citrate fermentation, proteolytic systems and protein metabolism in lactic acid bacteria; Genetics of starter bacteria: plasmids and plasmid instability; industrially significant genes; genetic modification of lactic acid bacteria through transduction; conjugation; protoplast transformation; electroporation and chromosomal integration, transposons and insertion sequences.
Unit III
Technology of starter cultures: Classification of starters; Single, mixed and multiple strain, mesophillic and thermophillic starter cultures; propagation and preservation of starter cultures; commercial starter preparations: concentrated and super concentrated starters; production systems for bulk cultures: Lewis, Jones and Tetra-pack systems; growth media: nutritional requirements of lactic acid bacteria, growth media formulations; PIM/PRM, pH control during culturing- external and internal pH control systems; preservation of bulk starter cultures- frozen and freeze dried, spray dried cultures; direct vat starter cultures
Unit IV
Starter failure and inhibition: Growth inhibition of lactic acid bacteria by antibiotics, bacteriocins; bacteriophages, cleaning and sanitizing agents and naturally occurring antimicrobial systems in raw milk; sources, types and characteristics of phages associated with starters, morphology an taxonomy, phage host interaction, prevention and control of phages during starter handling and fermented milk products manufacturing, mechanisms of phage resistance in lactic acid bacteria, inhibitory substances produces by lactic acid bacteria.
Unit V
Microbiology of fermented dairy products: Classification of fermented milks: lactic, yeast-lactic, mold-lactic fermented milk products; role of starter cultures in manufacturing of Dahi, Lassi, Yoghurt, acidophilus milk, cultured buttermilk, Koumiss, Kefir and chesses: microbiology of fresh and ripened cheeses, accelerated cheese ripening; Microbiological spoilage and safety of fermented dairy products; concepts of probiotics, prebiotics, synbiotics, bioactive milk peptides and their application in value addition in fermented dairy products.
Practicals
- Isolation of lactic acid bacteria from fermented milks products.
- Examination of purity and activity of starter cultures.
- Preservation of starter cultures by freeze drying and other methods.
- Preparation of concentrated starters and quality evaluation.
- Inhibition of starters by antibiotic residues and other inhibitors.
- Production of bacteriocine by lactic acid bacteria.
- Preparation and quality evaluation of dahi, lassi, yoghurt and kefir
- Examinations of microbial changes during ripening of cheddar cheese
Suggested Readings
- Wood BJ & Warner PJ. (Eds.). 2003. Genetics of Lactic Acid Bacteria. Springer- Verlag.
- Marth EH and Steele JL Applied Dairy Microbiology.Marcel Deker Inn. New York.
- Prajapati, J. B. and Behare, P. V. (2018). Textbook of Dairy Microbiology: Microbiology of Starter Culture Page no. 147-183. Published by Directorate of Knowledge Management in Agriculture, ICAR, ISBN: 978-81-7164-182-6.
- Barbara Speranza, Antonio Bevilacqua, Maria Rosaria Corbo and Milna Sinigaglia (2017). Starter Cultures in Food Production. Wiley Black Well, John Wiley & Sons, Ltd, UK.
- M. T. El-Mansi, C. F. A. Bryce, Arnold L. Demain, A.R. Allman (Edited) (2012) Fermentation Microbiology and Biotechnology, Third Edition CRC.
- Paul McSweeney Patrick Fox Paul Cotter David Everett (eds.) (2017). Cheese – Chemistry, Physics and Microbiology, 4th Academic Press.
DM 622 Microbial Genetics
Objective
To understand the fundamentals of structure, functions and synthesis of macromolecules and their genetic manipulation.
Theory
Unit I
Introduction and History, Macromolecules: DNA, RNA, their structure, types, organization, function and their properties, DNA replication
Unit II
Gene Expression and its regulation in Prokaryotes – Transcription Genetic Code Translation and; Negative and positive regulation of gene expression; Operon Models (lac)
Unit III
Mutations – Spontaneous and Induced Types of mutations, Mutagenic agents – Chemical, Damage and Repair systems operating in prokaryotes
Unit IV
Plasmids and their properties, transposable elements; Bacterial Recombination-Transformation, Conjugation and Transduction
Unit V
Fundamental aspects of genetic engineering/ recombinant DNA technology – Resriction enzymes, Plasmid Vectors (cloning as well as expression vectors), PCR and Real Time PCR; Application of genetic engineering in dairy and food industry
Practicals
- Isolation and quantitative estimation of chromosomal DNA from E.coli and
- Lactobacillus by mini prep method.
- Isolation and quantitative estimation of chromosomal DNA from Lactobacillus by mini prep method
- Isolation of plasmid DNA from coli by miniprep method.• Calcium chloride induced transformation of E.coli hosts with plasmids
- Calcium chloride induced transformation of coli hosts with plasmids
- Curing of plasmids with chemical mutagens (Ethidium Bromide) and elevated temperature
- Induction of random mutations in coli / Lactobacillus either by UV irradiation or chemical mutagens
- Use of restriction enzymes cleavage and ligation of DNA fragments
- PCR based detection of microorganisms
- Demo of Real Time PCR machine
Suggested Reading
- Synder L & Champness W. 2003. Molecular Genetics of Bacteria. ASM Publ.
- Uldis N Streips & Ronald E Yasbin (Eds.). 2004. Modern Microbial Genetics. John Wiley & Sons.
- Watson JD. 2003. Molecular Biology of Genes. W.A. Benjamin.
- Principles and Techniques of Biochemistry and Molecular Biology (7th Edition, 2010), authored by Keith Wilson and John Walker and published by Cambridge University Press India Pvt Ltd.
- Bansal MP. 2012. Molecular Biology and Biotechnology: Basic Experimental Protocols. Teri Press – New Delhi.
- Molecular Biology of the Gene (2017) by James D. Watson, A. Baker Tania, P. BellStephen, Gann Alexander, Levine Michael and Losick Richard
DM-623 Microbiological Quality Assurance
Objective
To impart knowledge on requirements for establishment of quality assurance facilities in food industry
Theory
Unit I
Importance of Microbiological Quality and Safety Assurance System in Dairy Industry: Principles of Quality and Safety Management Systems; Process approach based QMS (ISO-9001) and applications of HACCP system in dairy industry; TQM tools and techniques including Six sigma, 5S principle, kaizen; Plant hygiene and sanitation in dairy industry.
Unit II
General principles for the establishment and application of microbiological criteria for dairy foods: Definition, purpose and components of Microbiological criteria; Mandatory and advisory criteria; Sampling methods; Two and three class attributes for sampling plan (ICMSF); Establishment of microbiological standards, guidelines and specifications for different milk and milk products recommended by ICMSF, Codex, PFA, BIS.
Unit III
Enumeration and detection of indicator organisms and dairy pathogens: Indicator Organisms; Selection criteria for their use as quality and safety indicators; Conventional and rapid detection methods including commercial detection kits for indicator organisms and pathogenic bacteria in milk and milk products.
Unit IV
Microbial bio-sensor for monitoring pathogens and non-microbial contaminants in dairy foods: Definition, history, basic characteristics, classification and components of microbial bio-sensors; Detector system i.e. Electrochemical; Optical; Mechanical devices; Application of microbial bio-sensor in monitoring pathogenic bacteria, antibiotic residues andaflatoxin M1 in milk and milk products.
Unit V
Establishment and accreditation of QA Lab in dairy processing unit: Introductory information on Quality assurance lab in dairy processing unit; Bio-safety definition, principles and safety levels; Standard microbiological practices, safety equipment (primary barrier), facility design (secondary barrier), medical surveillance criteria and biological waste disposal; FDA requirements for establishing biosafety laboratory in dairy industry and its accreditation as per ISO.
Practicals
- Conventional and rapid techniques for microbiological evaluation of dairy products for Aerobic plate count, Yeast & Mold Count, Psychrotropic, Thermoduric and Thermophilic count, Spore count, Dye reduction test, Direct Microscopic Count, Thermotolerant Coliform and Enterobacteriaceae
- Bacteriological analysis of dairy water for Aerobic plate counts and Coliform counts (MPN).
- Detection of faecal and non–faecal coliform and faecal streptococci in dairy plant.
- Detection of antibiotic residues, aflatoxin M1 in milk using biosensor based micro-techniques.
- Detection and enumeration of aureus, Bacillus cereus, E. coli, Salmonella, Shigella, Listeria monocytogenes in dairy products.
- Evaluation of HACCP system in the preparation of different milk and milk products.
- Evaluation of common sanitizing agents in dairy plant by capacity and suspension test.
- Microbiological tests for assessing equipments and personnel hygiene by rinse and swab techniques.
Suggested readings
- Brown M Stringer Microbiological, 2002. Risk Assessment in Food Processing. Woodhead Publishing 1st Edition
- Patel P. (Ed.). (2012). Rapid analysis techniques in food microbiology. Springer Science & Business Media.
- Food Microbiology Laboratory, (2004) Lynne McLands Borough and published by CRC Press, USA
- Bacterial Pathogenesis (1st edition, 2017) edited by Nordenfelt, Pontus, Collin, Mattias and published by Springer
- Ioannis S. Arvanitoyannis. 2012. HACCP and ISO 22000: Application to Foods of Animal Origin (Institute of Food Science and Technology Series). Wiley-Blackwell
- Onsando Osiemo. 2012. Food Safety Standards in International Trade: The Case of the EU and the COMESA. Routledge Publisher
DM- 624 Probiotics for Health Foods
Objective
To familiarize the students with the concept of probiotics and their application in human health
Theory
Unit I
History and definition of Probiotics; Commercially available probiotic strains and probiotic dairy products
Unit II
Selection and identification of new strains of probiotics: Isolation of probiotic organisms from different niches; selection on the basis of probiotic attributes as per FAO/WHO guidelines; Identification of probiotics by molecular tools like PCR and 16S rRNA sequencing; DNA Finger printing by RAPD and Ribotyping
Unit III
Mechanism of action of probiotics: Colonization in the gut; Adhesion to intestinal mucosal surface – role of surface proteins; Production of antimicrobial substances – organic acids, hydrogen peroxide, bacteriocins; Pathogen exclusion; immuno-modulatory action; Impact on gut microbial balance; Host microbe interaction and their cross talk; Role of biomarkers for probiotic functionality
Unit IV
Application in Human Health and Disease: Probiotics for management of diseases – gastro-intestinal and antibiotic associated diarrohea; Inflammatory diseases such as Inflammatory Bowel disorder, Ulcerative colitis and Crohn’s; Respiratory, Urogenital, Life style, Allergy; Liver, AIDS / HIV, Cancer and antitumor effects
Unit V
Dairy based foods as carrier of probiotics: Dairy based products as delivery vehicles – Stability towards manufacturing conditions, enhancing stability through encapsulation or drying strategies for lyophilized formulations etc., co-culture compatibility with starters, minimum effective dose, large scale production of probiotic biomass through fermentation for application in foods and as drugs / supplements
Unit VI
Designer probiotics: Genetically modified probiotics as oral vaccines, enhanced adhesion properties and health promoting functions
Unit VII
Safety, human trials and regulatory guidelines: In vitro and in vivo safety assessment of probiotics; designing human trials; regulatory guidelines – US, Canada, Europe and India
Practicals
- Isolation of probiotic organisms from human milk and faecal samples
- Tentative identification by microscopic examination, catalase and biochemical tests
- Identification of isolates by genus and species specific PCR
- Evaluation of bacterial isolates for probiotic properties
- Acid tolerance; Bile tolerance; Hydrophobicity; Antimicrobial activity
- Survival of probiotic culture in fermented dairy products
- Microencapsulation of probiotic bacteria
Suggested Reading
- GB Huffnagle. 2008. The Probiotics Revolution: The Definitive Guide to Safe, Natural Health Solutions Using Probiotic and Prebiotic Foods and Supplements. Bantam, USA.
- Robert Keith Wallace (Author), Samantha Wallace 2017. Gut Crisis: How Diet, Probiotics, and Friendly Bacteria Help You Lose Weight and Heal Your Body and Mind. Dharma Publication, Fairfield, USA.
- Min-Tze Liong. 2011. Probiotics: Biology, Genetics and Health Aspects. Springer.
- Probiotics and Prebiotics in Animal Health and Food Safety (2018) by Di Gioia, Diana. -Biavati, Bruno.
- Probiotics and Prebiotics: Current Research and Future Trends (2015) by Koen Venema
- Probiotics in Food Safety and Human Health (2006) by Goktepe, Ipek. -Juneja, Vijay K.-Ahmedna, Mohamed.
DM- 625 Research Techniques in Dairy Microbiology
Objective
To impart knowledge and skills related to microbiological analytical systems in microbiology and related sciences
Theory
Unit I
Microscopy: principles, design and functions of bright field, dark field, phase contrast and fluorescence microscope; principle, design and application of transmission and scanning electron microscopes for the study of sub-cellular organization and microstructure of dairy foods
Unit II
Techniques for protein analysis and other molecular separation: electrophoresis, chromatography, ultracentrifugation; Enzyme analyses and substrate determination methods
Unit III
Molecular Biology Techniques for nucleic acid analysis: amplification, investigation of mutations and gene expression
Unit IV
Aerobic and Anaerobic culturing techniques for isolation of obligate and facultative organisms
Unit V
Use of animal models in toxicity studies
Practicals
- Familiarization with the construction and design of a compound microscope; use of light microscope accessories; microscopic analysis of different types of bacteria by bright field and dark field; phase contrast and fluorescence microscopes
- Disruption of bacterial cells by ultra-sonification
- Demonstration of chromatographic techniques
- Demonstration of aerobic and anaerobic culturing techniques
- Demonstration of use of animal models in toxicity studies,
- Demonstration of PCR technique as a tool for identification and characterization of microorganism
Suggested Readings
- Douglas B. Murphy.2001.Fundamentals of light microscopy and electronic imaging, Wiley-Liss, inc., USA.
- John F. T. Spencer,& Allicia L Ragout Leo M. L. Nollet, Fidel Toldra. 2013. Food analysis by HPLC, Third edition, CRC press, Taylor and Francis group, Florida, USA.
- Leo M. L. Nollet, Fidel Toldra. 2013. Food analysis by HPLC, Third edition, CRC press, Taylor and Francis group, Florida, USA.
- A. Nasser Hajibagheri.1999. Electron microscopy methods and protocols, methods in molecular biology series, # 117.Humana Press Inc., Totowa, New Jersey, USA.
- Harisha. 2010. Biotechnology procedures and experiments handbook. Infinity science press LLC, Hingham, MA 02043, USA.
- Singer, S. 2001. Experiments in Applied Microbiology, Academic Press, New York, USA.
DM-626 Microbial Fermentation Technology
Objective
To disseminate recent information on basic and applied aspects of fermentation technology and its industrial application to the students along with hands on training.
Theory
Unit I
Introduction to fermentation. Historical perspective, Fermentation as a means for enhancing shelf life of foods and pickles.
Unit II
Rate of microbial growth and death, Fermentation kinetics, mass transfer diffusion, membrane transport, dialysis, nutrient uptake.
Unit III
Fermenter/ Bioreactor design, operation, measurement and control in fermentation. Aeration and Agitation in fermentation; Oxygen requirement, Adsorption coefficient bubble aeration, mechanical agitation, correlation between mass transfer coefficients and operating variables.
Unit IV
Types of fermentation, submerged / solid state, Batch / continuous fermentation. In situ sterilization, Scale up in fermentation, Product recovery, Role of Immobilization, Downstream processing for Recombinant proteins and bio-assays
Unit V
Industrial production of Lactic acid, Penicillin, Betagalactosidase, aminoacids, vitamins, ethanol.
Practicals
- Follow up of bacterial growth in batch culture. Different methods of microbial cultivation.
- Fermenter operation and measurement.
- Production of starters, baker yeast culture, alcohol, alcoholic beverages.
Suggested Readings
- Kulandaivelu, S. Janarthanan (2012). Practical Manual on Fermentation Technology. I K International Publishing House Pvt. Ltd;
- P F Stanbury Dr. Whitaker (2008) Principles of Fermentation Technology, Elsevier; 2 editions.
- Nduka Okafor, Benedict C. Okeke Modern Industrial Microbiology and Biotechnology (Text Book), Second Edition (2017), published by CRC press, USA
- Principles and Applications of Fermentation Technology.(2019) Edited by Arindam Kuila and Vinay Sharma John Wiley & Sons; 1 edition (18 March 2019)
5th Dean’s Committee Syllabus
DM-111 Fundamentals of Microbiology
Theory
Overview of history and scope of microbiology: Discovery of Microorganisms and Microscopy (types, working principles and applications); Theories of Biogenesis and abiogenesis; Contributions of Leeuwenhoek, Pasteur, Tyndal, Joseph Lister, Robert Koch, Edward Jenner and Alexander Fleming; Scope and application of microbiology in fields like Dairy, Food, Pharmaceutical, Industrial, Medical and agriculture. Classification of Microbes: Microbial classification systems, numerical taxonomy, General properties and principles of microbial classification, Whittaker’s five kingdom and Carl Woese’s three domain classification system; Systematics of bacteria and Bergey’s manual of systematic bacteriology, Phylogenetic tree. Procaryotic and Eucaryotic microorganisms: Structure and functions of prokaryotic cells; Differences between prokaryotes and eukaryotes; Differences between cell wall of Gram positive and Gram negative bacteria; Structure of Archeal cell wall. Microbial growth and nutrition: Bacterial growth curve; factors affecting growth of bacteria, direct and indirect methods of measurement of bacterial growth; Bacteriostatic and bactericidal agents; Common nutrient requirements and nutritional types of microorganisms. Diversity of Microorganisms: Viruses: Structure and Classification; Bacteriophages; Differences between viruses and bacteria; Fungi: Classification of Fungi; Reproduction in Fungi; Protozoa and algae. Microbial Ecology and Environmental Microbiology: Microflora of air, soil and water and Microbes of Extreme environment like Archea. Basics of Microbial Genetics and Host-Microbe interactions: DNA as the genetic material, Structure of DNA/ RNA, DNA replication, transcription and translation; Basic concepts of immunology; Role of immune system in governing host-microbe interactions, Microbial Commensalism, Colonization, Infection, Disease and Vaccines
Practicals
- General instruction for microbiological laboratory.
- Microscope- simple and compound;
- Microbiological equipments; autoclave, hot air oven, incubator, centrifuge, colorimeter, laminar airflow, membrane
- Simple staining- methylene blue; crystal violet; negative staining.
- Differential staining (Gram, spore, acid fast).
- Motility of microorganisms – hanging drop technique.
DM-122 Microbiology of Fluid Milk
Theory
Microbes associated with raw milk: Significance of specific groups of microorganisms in milk i.e. psychrotrophic, mesophilic, thermoduric and thermophillic bacteria – their morphological and biochemical characteristics and classification. Microbial contaminants in raw milk, their sources during various stages of production – milking, chilling, storage and transportation with special reference to psychrotrophic microorganisms; Microbiological changes in bulk refrigerated raw milk. Sources of contamination and microbial spoilage of raw milk: Microbial contaminants of raw milk supplies, their sources during various stages of production i.e. milking, chilling, storage and transportation with special reference to psychrotrophic microorganisms and preventive measures. Types of microbial spoilage – souring, curdling, bitty cream, proteolysis, lipolysis, abnormal flavors and discolouration. Mastitis milk – types of mastitis, causative micro-flora of mastitis, compositional and microbiological changes during mastitis infection, their processing and public health. Concept of clean milk production: Hygienic milk production system; Cleaning and sanitation of udder, animal, utensils, equipments and dairy farm environment; Microbiological quality of milk produced in organized and un-organized sector in India and comparative information in developed world; Microflora of aseptically drawn milk and its natural antimicrobial systems – immunoglobulins, lactoferrin, lysozyme and lactoproxidase (LP) system. Microbiological aspects of fluid milk: Pasteurization, boiling, sterilization, ultra high temperature (UHT), non thermal (pulsed field) micro-filtration, bactofugation, standardization and homogenization. Significance of heat resistant and post processing contaminants in fluid milk with special reference to proteases and lipase enzymes and their role in spoilage of processed milk. Bio-film formation during processing and their control measures. Public health aspects of fluid milk: Microbial zoonotic diseases transmitted through fluid milk; Milk borne diseases -food infection, intoxication and toxi- infection caused E. coli, Salmonella typhi, Staphylococcus aureus, Bacillus cereus, Listeria monocytogenes, Shigella species, Campylobacter etc. Microbiological grading and legal standards of raw and processed milk.
Practicals
- Morphological examination of common dairy microorganisms (size and shape, arrangement and sporulation).
- Estimation of microbial load in raw milk by standard plate count (SPC) and dye reduction tests (MBRT, RRT).
- Grading of processed/ market milk by total viable count, coliform and methylene blue reduction time.
- Enumeration of psychrotrophic, thermophillic, thermoduric and spore forming bacteria in raw and market milk.
- Detection of sources of contamination: Air, water, utensils, equipment and personnel, line testing.
- Spoilage of milk caused by microorganisms: souring, sweet curdling, gassiness, lipolysis, ropiness, proteolysis and discolouration.
- Detection of mastitis milks: pH, SLST, somatic cell count, chloride content, Hotis test and CAMP test.
- Detection and estimation of coliforms: presumptive, rapid coliform and IMViC Test.
DM-221 Starter Cultures and Fermented Milk Products
Theory
Types, metabolism and propagation of starter cultures:History, classification and importance of starter Cultures in dairy industry; Single, multiple, defined and mixed strain starters; Probiotics and Special cultures like exopolysaccharide production; Propagation of starter cultures-concentrates – direct bulk and direct vat starter cultures, factors affecting propagation; Metabolism of starter cultures (carbohydrate, protein, citrate) and production of metabolites and antibacterial substances; methods of starter distillates their merits/demerits.
Activity, Purity, Preservation of Starters and Starter Failure:Quality and activity tests for dairy starters and their preservation- methods (liquid, spray drying, vacuum drying, freeze-drying, frozen concentrate, concentrated dried cultures), merits and demerits; factors affecting the survival of cultures during preservation; Defects in starters and their control; Starter failures- effect of antibiotic residues, sanitizers and bacteriophages. Phages-life cycle, sources, prevention, chemical and mechanically protected systems. Role of Starters in fermented milks:Role of starters in the preparation of various fermented milks; Types of fermented milks – dahi, yoghurt, acidophilus milk; different types of dahi and yoghurt; preparation; defects and their control. Kefir and koumiss : origin and characteristics; microbiology of kefir grains; Other fermented milks such as Bulgarian milk, cultured buttermilk, Leben, Villi and Yakult; Microbiology of fermented milk products; their nutritional and therapeutic significance. Chesse Starters:Classification, desirable properties, Artisanal and adjunct cheese cultures, primary and secondary flora of cheese; biochemical changes during ripening, bacterial and mold ripened cheeses: soft, semi-soft, semi-hard, hard, Brick and Brie cheese, Camembert and Roquefort cheese; Rennet: rennet substitutes, microbial rennet and recombinant chymosin.
Practicals
- Testing purity of starter cultures by gram’s staining, catalase test; creatine test.
- Testing starter activity by dye reduction tests, Horrall-Elliker, WhiteHead& Cox test.
- Preparation of single and mixed starter cultures.
- of homo-fermentation and hetero-fermentation separately and in combination.
- Preservation of starter cultures by freeze-drying techniques.
- Preparation of concentrated starter (DVS).
- Effect of physical factors (temperature, pH, Salt and Sugar) on dairy starters.
- milk for presence of inhibitory substances using stearothermophilus and S. thermophilus as indicator organisms
- Effect of presence of antibiotic residues in milk on starter activity.
- Evaluation of associative growth of Starter cultures in milk.
- Detection of Bacteriophages in cheese whey by plaque assay method.
- Preparation and microbial examination of dahi, yoghurt, cultured butter milk, acidophilus milk and kefir.
- Analysis of cheese for total spore and anaerobic spore count.
- Microbiological analysis of cheddar cheese at different stages of manufacture of (storage and ripening).
DM-222 Microbiology of Dairy Products
Theory
Microbiology of Cream and Butter – Micro-environment and impact of critical process factors on entry of spoilage and pathogenic organisms in cream and butter; Microbiological aspects including defects in pasteurized (ripened/unripened cream), sterilized and UHT cream; Factors influencing the microbial growth during batch/continuous butter making process; Microbial Defects in butter – Bacterial/mold discoloration, enzymatic deterioration and their control measures; Regulatory microbiological standards. Microbiology of Condensed, Evaporated and Dried products: Type of microorganisms associated with condensed, evaporated and dried products, their growth/ survival during manufacture and storage; Microbial defects – Bacterial thickening / Mold button formation in SCM; Gassiness/bloating, Bacterial coagulation (Sour and sweet), Bitterness, Fishy flavor in evaporated milk; pre-heating/DSI temperature and their impact on microflora of dried products; Effect of reconstitution on microbial quality of milk powder including baby foods and survivability of pathogens; Regulatory microbiological standards
Microbiology of Ice Cream and Frozen desserts: Microenvironment in ice cream, microbiological quality of ingredients, critical process factors and their impact on entry of pathogens in ice cream and frozen desserts, their survival during storage, food poisoning out breaks and legal standards. Microbiology of Indigenous Milk Products: Predominance of spoilage and pathogenic organisms in khoa and khoa based sweets – burfi, peda, gulabjamun, etc., paneer, Chhanna and Chhanna based sweets – rasogulla; kheer, shrikhand, dahi, kulfietc.; Factors affecting the microbiological quality in reference to production, processing, storage and distribution; Microbial safety in relation to potential pathogens and their public health significance; Microbial defects, control measures and legal standards; Active packaging concepts and role in bio-preservation.
Practicals
- Microbiological examination of raw, pasteurized, sterilized and UHT cream for Standard plate count (SPC) as well as lipolytic and coliform counts, direct microscopic count (DMC), dye reduction tests and sterility test.
- Microbiological examination of salted and unsalted butter for SPC, psychrotrophic, lipolytic, coliforms and yeast and mold count; K.Q test.
- Microbiological examination of concentrated milk for SPC, coliforms, spores, yeast and mold, thermoduric and thermophilic counts.
- Microbiological examination of dried milks for SPC, coliforms, aureus, B. cereus, E. coli, Salmonella, Sulphite reducing clostridia and Staphylococcal enterotoxins.
- Microbiological examination of ice-cream and other frozen desserts for SPC, coliforms and Staphylococcal counts; Detection of Salmonella spp./E. coli.
- Microbiological examination of khoa for SPC, coliforms and staphylococcal counts besides yeast and mold counts.
- Microbiological examination of paneer and shrikhand for SPC, Spores, coliforms, yeast and molds and Staphylococcal counts. Microbiological examination of packaging materials for SPC, Spores and Yeast and mold counts.
DM-311 Quality and Safety Monitoring in Dairy Industry
Theory
Consumer Awareness about Microbiological Quality and Safety of Dairy Foods: Changing scenario; Concepts of quality control, quality assurance and food safety; Global quality and food safety standards, Integrated food law, its main features and functions. Introduction to FoodSafety Management System: Concepts of Quality Management System (QMS)–ISO: 9000:2000; Principles of QMS; Standard requirements for QMS; HACCP concept and principle with special reference to biological hazards in dairy foods, TQM tools and techniques. Microbiological RiskAnalysis Concepts:Risk assessment, risk management and risk communication; risk profiling of dairy products; Microbiological criteria and two and three class sampling plan / guidelines; Bio-safety concepts in handling of dairy pathogens and setting up of a microbiological/ pathogen lab in a dairy plant. Rapid Enumeration Techniques: Enumeration principles and procedure for rapid detection of predominant hygiene indicator organisms and pathogens like E. coli (E. coli 0157:H7), Salmonella, Shigella, Staphylococcus aureus, Bacillus cereus and Listeria monocytogenes. Role of Biosensors for monitoring hygiene and safety of dairy foods: Detection of antibiotic residues in milk –Delvo SP, MDR test, penzyme test, charm assay, lateral flow assay (ROSA test) etc. Detection of aflatoxins, pesticides other inhibitors etc. and their public health importance in dairy foods. Plant and equipment hygiene:Concepts of hygiene and sanitation, microbial quality of water and environmental hygiene in dairy plant, chlorination of dairy water supply, quality of air, personnel hygiene, treatment and disposal of waste water and effluents.
Practicals
- Rapid detection of total plate count, yeast and mold counts, Coliform, coli, Enterococci, Enterobacteriacae count using D- count and 3M Petrifilm kits.
- Rapid detection of pathogenic bacteria based on antigen antibody principle: Staphylococcal enterotoxins, E. coli O157:H7, Listeria monocytogenes and Salmonella using VIDAS system.
- Rapid detection of antibiotic residues in milk usingDelvo SP, MDR test, Charm assay, Lateral flow assay (ROSA test).
- Rapid detection of aflatoxin M1/ pesticides residues in milk usingCharm Assay, Lateral Flow Assay (ROSA test) / Enzyme Inhibition Assay using Luminometer.
- Evaluation of common sanitizing agents used in dairy plants by a) suspension b) capacity test.
- Microbiological tests for assessing Environmental, equipment and personnel hygiene by swab and rinse methods
- Determination of BOD in dairy waste water.
- Quality evaluation by HACCP in the preparation of dairy products.
DM-321 Food and Industrial Microbiology
Theory
Scope of food microbiology: Basic aspects, history and scope of food microbiology. Intrinsic and extrinsic factors that affect microbial growth in different foods.
Microbial Spoilage of foods: Microbial spoilage of fruits, fruit juices, vegetables, cereals, meat, poultry, sea foods, carbonated soft drinks, canned foods; Sources of contamination; Control of spoilage. Food preservation: Principles of food preservation: physical methods viz. low temperature and high temperature preservation (D, Z and F Values); Drying Methods; Chemical preservatives, Natural antimicrobial compounds and bio- preservation; Mode of action of various preservation methods on microbes. Fermentation processes: Fermentation processes : Historical development, the range, components and types (i.e. submerged, surface and solid state fermentation); criteria for selection of industrially important microorganisms; preservation and improvement of industrially important micro-organisms using metabolic engineering/genetic engineering; media for industrial process; upstream and downstream processing. Types of fermenters: Fermenters: types (batch, fed batch and continuous), functions, design and control; sterilization; growth rate analysis, estimation of biomass; difference in chemostat and turbidostat. Microbial production of industrial products: Immobilization of enzymes/cells; Microorganisms and processes involved in the production of single cell protein and industrial alcohol, beer and wine; organic acids (citric and lactic), enzymes (protease, lipase and rennet), vitamin (B12), antibiotics and bacteriocins; and fermented whey beverages.
Practicals
- Microbiological examination of: 1) fresh and canned fruits, vegetables and juices; 2) flour and bread; and 3) eggs and meat.
- Isolation of psychrophilic, salt and sugar tolerant microorganisms from foods.
- Isolation of industrially important microorganisms from environment.
- Determination of Z, D and F values.
- Production and assaying of microbial enzymes (protease/ lipase).
- Production of lactic acid from whey.
- Production of nisin and assaying the antimicrobial activity of the culture.
- Design and control of a table-top and 10 liter lab fermenter (Demonstration).
- Production of ethyl alcohol from molasses and whey by yeasts.
- Production of fermented whey beverages.
- Educational tour to food processing/ fermentation industries.
Syllabus of Food Safety and Quality Assurance (FSQA) Courses
Ph. D Courses
FS-723 Advances in Food Safety of Dairy Foods
Objectives
To impart current knowledge pertaining to microbial risk assessment of dairy pathogens and their safety concern in dairy foods.
Theory
Unit I
Milk borne diseases, epidemiology and surveillance in dairy products: Current trends, incidence and surveillance of milk borne diseases; Changing patterns in epidemiology, agricultural and food manufacturing practices, transmission and susceptibility.
Unit II
General mechanism of microbial pathogenesis: Food borne infection by colonization and adhesion factors like pilli or fimbriae, adhesion proteins, biofilm formation; Invasion and intracellular residence; Phagocytosis, invasion mediated induced phagocytosis; Iron acquisition; Motility and chemotaxis, invasion of immune system; Intoxication; Toxi-infection, structure and function of exotoxins and endotoxin; Genetic regulation and secretary system for virulence factors.
Unit III
Risk assessment of dairy pathogen: Growth and survival characteristics of dairy pathogens namely E. coli, Cronobacter (Enterobacter) sakazaki, Salmonella, Shigella, Yersinia enterocolitica, Streptococcus sp., L. monocytogenes, Mycobacterium avium subsp. paratuberculosis, Brucella sp., Campylobacter jejuni, Staphylococcus aureus, Bacillus cereus, Clostridium perfringens, toxigenicfungi and viruses in milk and milk products, their pathology of illness, mode of transmission, incidence of illness, virulence and infectivity.
Unit IV
Microbiological risk profile of dairy foods: Hazard identification and characterization in dairy products; Evidence of antimicrobial resistant bacteria in milk and milk products; Risk factors affecting microbial safety of raw and processed dairy foods; Exposer assessment and risk characterization; Attribution of food-borne illness to dairy products; Risk management issues and control strategies for dairy products.
Suggested Readings
- Bhunia AK 2008 Foodborne Microbial Pathogens: Mechanisms and Pathogenesis. Purdue University West Lafayette, IN, USA.
- Antimicrobial Resistance in Bacteria from Livestock and Companion Animals (2018). Stefan Schwarz (Professor of veterinary medicine), Lina Maria Cavaco, Jianzhong Shen, Frank M. Aarestrup and published by ASM Press
- Quantitative Microbial Risk Assessment. Charles N. Haas, Joan B. Rose, Charles P. Gerba John Wiley & Sons, 09-Jun-2014 – Technology & Engineering.
- Indira T. Kudva, Tracy Nicholson (2016). Virulence Mechanisms of Bacterial Pathogens. ASM Press.
- D. Scott McVey, Melissa Kennedy, M. M. Chengappa (2013). Veterinary Microbiology John Wiley & Sons,
- Charles Yoe (2016). Principles of Risk Analysis: Decision Making Under Uncertainty. Publisher – Technology & Engineering
- William HS and Michael PD 2009 Compendium of the Microbiological spoilage of food and Beverage. Springer Science. Heidelberg, London.
M.Tech Courses
FS- 611 Basic Concepts of Quality Assurance and Food Safety System
Objective
To imparts training for basic concepts of quality assurance and food safety system in food industry.
Theory
Unit I
Concepts of Quality Control, Quality Assurance and Food Safety: Basic Definition and Terminology; new quality and food safety approaches: The Changing Scenario; Global Considerations- Codex Alimentarius Commission (CAC); Sanitary and phytosanitary standards (SPS) and Technical to Barrier and Trade (TBT) Agreements; Quality control Vs. Quality assurance; Concepts of Hygiene and Sanitation: Good Agriculture Practices (GAP) / Good Hygiene Practices (GHP) / Good Manufacturing Practices (GMP) / Good Distribution Practices (GDP) concept etc.
Unit II
HACCP concept and principle: History and steps involved in application of HCCP in dairy unit; Establishment of a multi-disciplinary HACCP team; Product description; Identify intended use; Construct a process flow diagram; On-site verification of process flow diagram; Principles of Hazard Analysis and Critical Control point (HACCP) Concepts; HACCP plans and implementation of Operation Risk control; CCPs’, Traceability; Example of HACCP application in liquid milk; ice cream, pasteurised butter; dried products, cheese, cereals, fruits and vegetables, meat and meat products etc.
Unit III
Introduction to Quality Management Systems (QMS): Basic Definition and Terminology; Structure and General Principles; Benefits of applying QMS in food unit; ISO: 9000:2000–QMS Fundamentals and Standards; Guidelines for performance.
Unit IV
Concepts, principle and Standard Requirements of QMS–ISO 9000:2000: Process-based QMS concept and Principles; Key benefits of its Application into process, product and system; Standard requirements for QMS – ISO 9001:2000; Food Safety Management System (FSMS) – ISO 22000: Requirements; Goal of ISO 22000 and Methodology; Prerequisite programs (PRPs); Operational prerequisite programs (OPRPs); application of QMS in food processing unit with practical examples.
Unit V
TQM tools and techniques: Six Sigma methodology (DMAIC and DMADV); Lean Manufacturing; Lean Six Sigma; Kaizen; Total Productive Maintenance (TPM); 5S principle; PDCA Cycles; Quality circles.
Unit VI
Environmental and Laboratory Management System: Evolution, concept, policies and Elements of EMS, Requirements of ISO 14001 and its methodology development and implementation; Laboratory Management System (LMS) as per ISO 17025; History, Fundamental of Laboratory Organization/Management, Quality Assurance and Designing; NABL Accreditation of Food Laboratory.
Unit VII
Management Systems Auditing: Audit as per ISO 19011; Audit Types and process, Key stages during Auditing: Initiating the Audit, Pre-assessment visits, Document Review, Preparing for On-site Audit activities, Reporting on Audit, Non-conformity Report, Audit Completion, Corrective Action, Follow-up and Surveillance visits.
Unit VII
Statistical Quality Control (SQC): Principle and concept of SQC; Definition of SQC program standards, Precision; Accuracy; Variability Displaying Data; Control Charts; Pareto analysis; Rating Scales etc.
Practicals
- Microbiological tests/ rapid assessment of equipment’s, personnel and environmental hygiene in a food processing unit.
- Hazard analysis and CCPs determination for milk and food products: liquid milk; ice cream, pasteurized butter; dried products, cheese, cereals, fruits and vegetables etc.
- Development of HACCP plan for CCPs monitoring, correction and preventive action schedule preparation and documentation.
- Identification of clauses; planning pre requisite programme (PRPs); and OPRPs for ISO 22000: 2005 implementation in dairy unit.
- Preparation of audit schedule and to conduct an internal audit on QMS, HACCP and laboratory management system.
- Development of quality Plan for Kaizen; 5S principle and their implementation in food processing unit.
- Control charts and Pareto analysis of standard plate count and coli in indigenous dairy products.
- Visit to any food processing plant for QMS/HACCP demonstration under field condition.
Suggested Readings
- Chandan R. C., Kilara A. and Shah, N. (Eds.). (2009). Dairy processing and quality assurance. John Wiley & Sons.
- Haider S. I. (2011). Environmental management system 14001: 2004. Hand book of transition with CD ROM. CRC Press Taylor & Francis group.
- Herschdoerfer S. (Ed.). (2012). Quality control in the food industry (Vol. 2). Elsevier.
- International Standards ISO 22000. Food safety management systems- requirements for any organization in the food chain. Ref. No. 22000-2005 (E). Switzerland.
- International Standards ISO 9001. Quality management systems- Requirements for any organization. Reference number ISO 9001:2008 (E) Switzerland.
- ISO 14001:2004 Environmental management systems – Requirements with guidance for use.
- ISO 14001:2004, Environmental management systems-Requirements with guidance for use.
- ISO 19011:2002, Guidelines for quality and/or environmental management systems auditing.
- ISO 2007, The ISO survey of ISO 9000 and ISO 14000 Certifications: 16th cycle, ISO, Geneva.
- ISO/IEC 17011: 2004; Conformity assessment, general requirements for accreditation bodies accrediting conformity assessment bodies.
- ISO/IEC 17025: 2005; General requirements for the competence of testing and calibration laboratories.
- ISO/IEC 17025:2005. General requirements for the competence of testing and calibration laboratories
- Jay J. Schlickman (2003). ISO 9001:2000 Quality Management System Design. ARTECH House Inc. Norwood, MA 02062. ISBN No. 1-58053-526-7.
- Kalia M. (2010). Food Quality Management (Incorporates ICAR recommended syllabus). Agrotech Publishing Academy, Udaipur. ISBN 978-81-8321-162-8.
- Keen M., Brown V. A., and Dyball, R. (2005). Social learning in environmental management: towards a sustainable future. Routledge.
- Lelieveld H., Holah J., and Napper D. (Eds.). (2014). Hygiene in food processing: principles and practice. Elsevier.
- Marsden T., and Morley A. (Eds.). (2014). Sustainable food systems: building a new paradigm. Routledge.
- McPherson R. A., and Pincus M. R. (2011). Henry’s clinical diagnosis and management by laboratory methods. Elsevier Health Sciences.
- Michael E. and Deen P.E. (2010). Quality Manual and Quality Procedures for ANSI/ISO/IEC 17025: Assistance in Achievement of Accreditation.
- Mortimore S. E. and Wallace C. A. (2015). HACCP: A Food Industry Briefing. John Wiley & Sons.
- Motarjemi Y. and Huub Lelieveld (2013). Food Safety Management: A Practical Guide for the Food Industry. Acedemic Press, San Diego (USA). ISBN 978-0-12-381504-0.
FS- 612 Risk Analysis Concept and Regulatory Food Standards
Objective
To understand the concepts and procedures for risk assessment and analysis as well as legal aspects in food sector
Theory
Unit I
Risk Analysis Concept in food chain: Definition and Terminology– Concept of Risk Analysis; Risk assessment -Hazard identification; Exposure assessment; Hazard characterization; Risk characterization; Risk management; Risk communication; Qualitative and Quantitative Risk assessment for pathogenic bacteria and their toxins; Microbiological risk profile: Concepts; Scope and Purpose; ICMSF ranking scheme of categorization of Hazards; Risk Ranking of Dairy Products; Risk Management Issues and Control Strategies for dairy and other food products.
Unit II
Risk Assessment of Food Pathogens: Growth and survival characteristics of pathogens – E. coli, Enterobacter sakazaki, Salmonella, Shigella, Yersinia enterocolitica, Streptococcus sp., Listeria monocytogenes, Mycobacterium avium subsp. paratuberculosis, Brucella sp., Campylobacter jejuni, Staphylococcus aureus, Bacillus cereus, Clostridium perfringens in dairy foods, their pathology of illness, mode of transmission, incidence of illness, virulence and infectivity; Risk assessment models for dose response and exposer assessment; Antimicrobial resistant in bacteria.
Unit III
Microbial Pathogenesis associated with foods: Current trends, incidence and surveillance of food borne diseases; Changing patterns in epidemiology, agricultural and food manufacturing practices, transmission and susceptibility; Food poisoning, food infections by colonization and adhesion factors, food intoxication and toxi-infections; structure and function of exotoxins, endotoxin and mycotoxins; Food borne pathogens implicated with human diseases, their sources, mechanism of pathogenesis and public health significance.
Unit IV
General Principles of food law/ Legislation: Definition of Food Legislation; General Food Law’; General Principles of Food Law; Integrated Food Law, Its Main Features and Functions; scope, provision, guidelines, rules, regulation and implementation; Duties and functions of the authority; Key Challenges for Speedy and Effective Implementation of Food Safety and Standard Act; Concept of appropriate level of protection (ALOP); food safety objectives (FSO); Understanding Codex Alimentarius Commission (CAC) and its working; codex standards for Food / food additives; Food and Drug Administration (FDA) and European Food Safety Authority (EFSA)
Unit V
Food Quality and Safety Standards: Definition of Food Standards, Specification and guidelines; Microbiological quality and safety standards for foods with special reference to milk and milk products; need for shifting to risk based assessment of foods for microbiological quality & safety; sampling and test methods and aspects related to sampling and testing of packaged foods, freshly cooked foods, and foods that require refrigeration during storage and transport.
Practicals
- Testing of food products for Hygiene Standards – SPC, coliform, faecal Streptococci; MBRT, Yeast and mold counts as per FSS regulation and 3-class sampling plan.
- Testing of food products for Safety Standards – coli, Salmonella, L. monocytogenes, B. cereus, S. aureus, Enterobacter sakazakii as per FSS regulation and 2-class sampling plan.
- Checking the compliance of Dairy Foods –pasteurized milk, cream, butter, ice cream, dried products, indigenous dairy products, fermented milks as per FSS regulation.
- Experiments on Exposer Assessment of different pathogens in food products at various stages in supply chain.
- To establish food safety objectives (FSO) for different pathogens based on Dose Response Studies/ Analysis.
Suggested Readings
- Bhunia A. K. (2008). Foodborne Microbial Pathogens: Mechanisms and Pathogenesis. Purdue University West Lafayette, IN, USA.
- Clive de W. B. and Peter J. M. (2002) Food Borne Pathogens, Hazards, Risk Analysis and Control. Wood Head Publishing In Food Science and Technology, Cambridge, UK.
- Early R. (2012). Guide to quality management systems for the food industry. Springer Science & Business Media.
- Food & Drug Administration (2004) Food Borne Pathogenic microorganisms and Natural toxins Handbook: The Bad Bug Book. International Medical Publishing, Inc., Mclean, Virginia. http://www.cfsan.fda.gov/egi-bin/printall.egi.
- Forsythe S. J. (2011). The microbiology of safe food. John Wiley & Sons.
- FSANZ (2006). A risk profile of dairy products in Australia. www.foodstandards.gov.au/_…/DAR_P296_Dairy_PPPS_Attach_2%20_App%20_1_6.pdf
- Hockling A. D. (2003) Food Borne Microorganisms of Public Health Significance. 6th Ed. AIFST (NSW Branch) Food Microbiology Group, Sydney.
- ICMSF (2002) Microorganisms in Foods 7: Microbiological testing in food safety management. Kluwer Academic/Plenum Publishers, New York.
- Jackson L. S., Knize M. G., & Morgan J. N. (Eds.). (2012). Impact of processing on food safety (Vol. 459). Springer Science & Business Media.
- Marth E. H. and Steele J. M. (2001). Applied Dairy Microbiology. 2nd Ed. Marcel Dekker, Newyork, USA.
- Phillips J. and Smith, D. F. (2013). Food, science, policy and regulation in the twentieth century: international and comparative perspectives (Vol. 10). Routledge.
- Swinnen J. F. (Ed.). (2007). Global supply chains, standards and the poor: how the globalization of food systems and standards affects rural development and poverty. Cabi.
- William H. S. and Michael P. D. (2009) Compendium of the Microbiological spoilage of food and Beverage. Springer Science. Heidelberg, London.
FS-613 Microbiology of Fluid Milk and Dairy Products
Objective
To impart current knowledge of basic and applied microbiological aspects of fluid milks and dairy products for improved quality and food safety.
Unit I
Common microbes in milk and their significance. Microflora of mastitis milk and its importance in dairy industry. Sources of microbial contamination of raw milk and their relative importance in influencing quality of milk during production, collection, transportation and storage. Clean milk production and antimicrobial systems in raw milk. Microbial changes in raw milk during long storage. Microbiological grading of raw milk.
Unit II
Microbiological aspects of processing techniques like: bactofugation, thermization, pasteurization, sterilization, boiling, UHT, non thermal processes (pulse field) and membrane filtration of milk. Role of psychrotrophic, mesophillic, thermophilic and thermoduric bacteria in spoilage of processed milks, their sources and prevention. Heat induced damage in bacteria and role of resuscitation in recovery of injured microbial cells. Microbiological standards (BIS/ PFA) of heat treated fluid milks.
Unit III
Microbiological quality of dairy products; fat rich (cream and butter), frozen (ice cream), concentrated (evaporated and condensed milk), dried milks (roller and spray dried), infant dairy foods and legal standards. Factors affecting microbial quality of these products during processing, storage and distribution. Microbiological defects associated with these products and their control.
Unit IV
Microbiological quality of traditional dairy products; heat desiccated (khoa, burfi, peda, kheer), acid coagulated (paneer, chhana, rasgulla), fermented (lassi, srikhand) and frozen (kulfi). Sources of microbial contaminants and their role in spoilage. Importance of personnel and environmental hygiene on quality of traditional milk products. Microbiological standards for indigenous dairy foods.
Unit V
Definition of food poisonings, food infections and toxi-infections, pathogens associated with fluid milks, dairy products and their public health significance. Sources of pathogens and their prevention. Importance of biofilms, their role in transmission of pathogens in dairy products and preventive strategies.
Practicals
- Grading of raw milk based on SPC, coliform and dye reduction tests.
- Effect of different storage temperatures on microbiological quality of fluid milk
- Tests for mastitic milk and brucellosis
- Microbiological quality evaluation of cream and butter for yeasts & molds, lipolytic and proteolytic bacteria.
- Detection of Enterobactersakazakii in infant dairy foods.
- Microbial evaluation of Burfi and Peda for SPC, yeast and mould counts.
- Detection of Bacillus cereus, Salmonella,Shigellaand coagulase positive staphylococci in milk powder
- Evaluation of ice cream for coliforms and coli
- Microbiological quality of Paneer
- Enumeration of aerobic and anaerobic spores in condensed and sterilized milk.
- Line testing for determining the source of contamination of dairy products.
Suggested Readings
- Osei. 2017. Handbook of Dairy Microbiology. AGri-Horti Press
- Palmiro Poltronieri (Editor) 2017. Microbiology in Dairy Processing: Challenges and Opportunities John Wiley & Sons Inc.
- Barbaros Eozer. 2014. Dairy Microbiology and Biochemistry: Recent Developments. CRC Press, USA
- B A Law. 2012. Microbiology and Biochemistry of Cheese and Fermented Milks. Springer Publisher.
- Rhea Fernandes (Editor). 2009. Microbiology Handbook: Dairy Products. RSC Publishing
Melanie Quin. 1989. Applied microbiology in the Dairy Industry. Hobsons Publishing PLC
FS-614 Food Microbiology
Objective
To understand microbial behaviour in different food matrices and their public health signficance
Unit I
Food Borne Micro-Organisms: Morphology of food related bacteria, yeast, mould,virus and their classification; Factors affecting growth of microorganisms in food: intrinsic factors- water activity, pH and buffering capacity, redox potential, nutrient content, antimicrobial constituents; extrinsic factors- relative humidity, temperature, gaseous atmosphere.
Unit II
General Principles Underlying Food Spoilage and Diseases: Source of contamination, types of food spoilage-proteolysis, lipolysis, hydrolytic rancidity etc.; Food Poisoning, food infection, intoxication; Food borne bacterial diseases;causative agents and sources, symptoms and prevention of Staphylococcal food poisoning, botulism, salmonellosis, Bacillus infection, E.coli etc. Food borne fungal diseases-ergotism, Aflatoxins; Food borne viral diseases-Hepatitis, Polio; Food born protozoal diseases – Amoebiasis.
Unit III
Microbiology of Processed Fruits, Vegetables, Cereals, Egg, Meat & Fish Products: Source of contamination; types of spoilage of raw and processed fruits and vegetables; micro-flora in cereal grains, flour, bread cake and pasta; spoilage of bread, cake and cereal products; micro-flora of egg, fish and meat, spoilage of egg, fish raw and canned meat; factors affecting growth and preservative principle of different products; microbial defects and their control measure.
Unit IV
Microbiology of Milk and Milk Products: Microorganisms associated with milk; source of contamination ; micro-environment of raw, pasteurized, sterilized milk, cream, butter, khoa, cheese, sweetmeats, canned foods and dried products; factors affecting growth and preservative principle of dairy products; Microbial defects and their control measure.
Unit V
Beneficial Microorganisms in Food Fermentation: Role of Lactic Acid Bacteria (LAB), Acetic acid bacteria, Propionic acid bacteria, Bifidobacteria in food fermentation; Dairy starter, preservation techniques, DVS preparation; role of starters in fermented food preparation-Dahi, Yoghurt,Bread, Wine, Cheese, sauerkraut etc.
Unit VI
Food preservation: Bio-preservation using microbial metabolites – Organic acid, Bacteriocins and enzymes. active packaging and antimicrobial packaging (AMP), modified atmosphere packaging (MAP), Hurdle concept; Alternate methods for controlling spoilage of foods: High Pressure Processing, Pulsed electric field (PEF) processing, Ultrasonic Food Processing, Ohmic Heating of Foods, Intense Pulse Light, Plasma Light, Oscillating Magnetic Fields (OMF)
Practicals
- Identification of microorganism –Bacteria, Yeast, mould,
- Simple staining, grams staining and hanging drop preparation.
- Microbiological examination of Pasteurised Butter;Ice cream and Dried products.
- Microbiological examination of fruits and vegetables
- Microbiological examination of bread and cake
- Microbiological examination of egg.
- Microbiological examination of canned foods.
- Production of fermented foods – Dahi, yoghurt, bread, sauerkraut.
- Activity and purity test for dairy starters.
- Production of bacteriocin and their role in bio-preservation of foods – paneer, khoa etc.
- Freeze drying of dairy starters /DVS culture.
Suggested Readings
- Adams M. R. and Moss M. O. (2008). Food Microbiology. 3rd Ed. RSC Publisher, Cambridge, UK.
- Banwart G. (2012). Basic food microbiology. Springer Science & Business Media.
- Cunningham F. (Ed.). (2012). Microbiology of poultry meat products. Elsevier.
- De Silva N., Taniwaki M. H., Junqueira V. C., Silveira N., do Nascimento M. D. S. and Gomes R. A. R. (2012). Microbiological examination methods of food and water: a laboratory manual. CRC Press.
- Forsythe S. J. (2011). The Microbiology of safe food. John Wiley & Sons.
- Frances P. D and Keith ITO (2001). Compendium of Methods for the Microbiological Examination of Foods. 4th Ed. American Public Health Association (APHA), Washington DC, USA.
- Gurtler J. B., Doyle M. P. and Kornacki J. L. (2014). The Microbiological Safety of Low Water Activity Foods and Spices. Springer.
- Hayes R. (2013). Food microbiology and hygiene. Springer Science & Business Media.
- Hoover D. G. and Steenson L. R. (Eds.). (2014). Bacteriocins of lactic acid bacteria. Academic Press.
- Hwang C. A. and Fan X. (2015). Processing, Quality and Safety of Irradiated and High Pressure-Processed Meat and Seafood Products. In Minimally Processed Foods (pp. 251- 278). Springer International Publishing.
- Jay J. M. (2012). Modern food microbiology. Springer.
- Owens J. D. (Ed.). (2014). Indigenous Fermented Foods of Southeast Asia. CRC Press.
- Patel P. (Ed.). (2012). Rapid analysis techniques in food microbiology. Springer Science & Business Media.
- Ray B. and Bhunia A. (2012). Fundamental Food Microbiology, 5th CRC Press.
- Tokuşoğlu Ö. and Swanson B. G. (Eds.). (2014). Improving food quality with novel food processing technologies. CRC Press.
- William H. S. (2009). Compendium of the Microbiological Spoilage of Foods and Beverages. Springer
FS-621 Microbiological Quality Assurance
Objective
To impart knowledge on requirements for establishment of quality assurance facilities in food industry
Theory
Unit I
Importance of Microbiological Quality and Safety Assurance System in Dairy Industry: Principles of Quality and Safety Management Systems; Process approach based QMS (ISO-9001) and applications of HACCP system in dairy industry; TQM tools and techniques including Six sigma, 5S principle, kaizen; Plant hygiene and sanitation in dairy industry.
Unit II
General principles for the establishment and application of microbiological criteria for dairy foods: Definition, purpose and components of Microbiological criteria; Mandatory and advisory criteria; Sampling methods; Two and three class attributes for sampling plan (ICMSF); Establishment of microbiological standards, guidelines and specifications for different milk and milk products recommended by ICMSF, Codex, PFA, BIS.
Unit III
Enumeration and detection of indicator organisms and dairy pathogens: Indicator Organisms; Selection criteria for their use as quality and safety indicators; Conventional and rapid detection methods including commercial detection kits for indicator organisms and pathogenic bacteria in milk and milk products.
Unit IV
Microbial bio-sensor for monitoring pathogens and non-microbial contaminants in dairy foods: Definition, history, basic characteristics, classification and components of microbial bio-sensors; Detector system i.e. Electrochemical; Optical; Mechanical devices; Application of microbial bio-sensor in monitoring pathogenic bacteria, antibiotic residues andaflatoxin M1 in milk and milk products.
Unit V
Establishment and accreditation of QA Lab in dairy processing unit: Introductory information on Quality assurance lab in dairy processing unit; Bio-safety definition, principles and safety levels; Standard microbiological practices, safety equipment (primary barrier), facility design (secondary barrier), medical surveillance criteria and biological waste disposal; FDA requirements for establishing biosafety laboratory in dairy industry and its accreditation as per ISO.
Practicals
- Conventional and rapid techniques for microbiological evaluation of dairy products for Aerobic plate count, Yeast & Mold Count, Psychrotropic, Thermoduric and Thermophilic count, Spore count, Dye reduction test, Direct Microscopic Count, Thermotolerant Coliform and Enterobacteriaceae
- Bacteriological analysis of dairy water for Aerobic plate counts and Coliform counts (MPN).
- Detection of faecal and non–faecal coliform and faecal streptococci in dairy plant.
- Detection of antibiotic residues, aflatoxin M1 in milk using biosensor based micro-techniques.
- Detection and enumeration of aureus, Bacillus cereus, E. coli, Salmonella, Shigella, Listeria monocytogenes in dairy products.
- Evaluation of HACCP system in the preparation of different milk and milk products.
- Evaluation of common sanitizing agents in dairy plant by capacity and suspension test.
- Microbiological tests for assessing equipments and personnel hygiene by rinse and swab techniques.
Suggested readings
- Brown M Stringer Microbiological, 2002. Risk Assessment in Food Processing. Woodhead Publishing 1st Edition
- Patel P. (Ed.). (2012). Rapid analysis techniques in food microbiology. Springer Science & Business Media.
- Food Microbiology Laboratory, (2004) Lynne McLands Borough and published by CRC Press, USA
- Bacterial Pathogenesis (1st edition, 2017) edited by Nordenfelt, Pontus, Collin, Mattias and published by Springer
- Ioannis S. Arvanitoyannis. 2012. HACCP and ISO 22000: Application to Foods of Animal Origin (Institute of Food Science and Technology Series). Wiley-Blackwell
- Onsando Osiemo. 2012. Food Safety Standards in International Trade: The Case of the EU and the COMESA. Routledge Publisher
FS-625 Research Techniques in Dairy Microbiology
Objective
To impart knowledge and skills related to microbiological analytical systems in microbiology and related sciences
Theory
Unit I
Microscopy: principles, design and functions of bright field, dark field, phase contrast and fluorescence microscope; principle, design and application of transmission and scanning electron microscopes for the study of sub-cellular organization and microstructure of dairy foods
Unit II
Techniques for protein analysis and other molecular separation: electrophoresis, chromatography, ultracentrifugation; Enzyme analyses and substrate determination methods
Unit III
Molecular Biology Techniques for nucleic acid analysis: amplification, investigation of mutations and gene expression
Unit IV
Aerobic and Anaerobic culturing techniques for isolation of obligate and facultative organisms
Unit V
Use of animal models in toxicity studies
Practical
- Familiarization with the construction and design of a compound microscope; use of light microscope accessories; microscopic analysis of different types of bacteria by bright field and dark field; phase contrast and fluorescence microscopes
- Demonstration of chromatographic techniques
- Demonstration of aerobic and anaerobic culturing techniques
- Demonstration of use of animal models in toxicity studies,
- Demonstration of PCR technique as a tool for identification and characterization of microorganism
Suggested Readings
- Douglas B. Murphy.2001.Fundamentals of light microscopy and electronic imaging, Wiley-Liss, inc., USA.
- John F. T. Spencer,& Allicia L Ragout Leo M. L. Nollet, Fidel Toldra. 2013. Food analysis by HPLC, Third edition, CRC press, Taylor and Francis group, Florida, USA.
- Leo M. L. Nollet, Fidel Toldra. 2013. Food analysis by HPLC, Third edition, CRC press, Taylor and Francis group, Florida, USA.
- A. Nasser Hajibagheri.1999. Electron microscopy methods and protocols, methods in molecular biology series, # 117.Humana Press Inc., Totowa, New Jersey, USA.
FS-626 Starter Cultures and Fermented Dairy Products
Objective
To familiarize the students with the starter organisms, their metabolism and genetics; different types of starters, propagation, preservation and applications of starters.
Theory
Unit I
Taxonomy and characteristics of starter cultures: Taxonomy and natural habitat of starter organisms; characteristics of starter organisms: Lactococcus, Leuconostoc, Streptococcus, Pediococcus, Lactobacillus, Bifdobacterium Enterococcus, Propionibacterium, Brevibacterium, yeasts and molds. Desirable properties of lactic acid bacteria for different fermented milk products.
Unit II
Metabolism and genetics of starter cultures: Carbohydrate, citrate and protein metabolism: lactose, galactose and glucose metabolism- transport of sugars across the cell boundaries, homolactic and heterolactic fermentation, other pathways of sugar metabolism, citrate transport and metabolism formation of flavouring agents from citrate fermentation, proteolytic systems and protein metabolism in lactic acid bacteria; Genetics of starter bacteria: plasmids and plasmid instability; industrially significant genes; genetic modification of lactic acid bacteria through transduction; conjugation; protoplast transformation; electroporation and chromosomal integration, transposons and insertion sequences.
Unit III
Technology of starter cultures: Classification of starters; Single, mixed and multiple strain, mesophillic and thermophillic starter cultures; propagation and preservation of starter cultures; commercial starter preparations: concentrated and super concentrated starters; production systems for bulk cultures: Lewis, Jones and Tetra-pack systems; growth media: nutritional requirements of lactic acid bacteria, growth media formulations; PIM/PRM, pH control during culturing- external and internal pH control systems; preservation of bulk starter cultures- frozen and freeze dried, spray dried cultures; direct vat starter cultures
Unit IV
Starter failure and inhibition: Growth inhibition of lactic acid bacteria by antibiotics, bacteriocins; bacteriophages, cleaning and sanitizing agents and naturally occurring antimicrobial systems in raw milk; sources, types and characteristics of phages associated with starters, morphology an taxonomy, phage host interaction, prevention and control of phages during starter handling and fermented milk products manufacturing, mechanisms of phage resistance in lactic acid bacteria, inhibitory substances produces by lactic acid bacteria.
Unit V
Microbiology of fermented dairy products: Classification of fermented milks: lactic, yeast-lactic, mold-lactic fermented milk products; role of starter cultures in manufacturing of Dahi, Lassi, Yoghurt, acidophilus milk, cultured buttermilk, Koumiss, Kefir and chesses: microbiology of fresh and ripened cheeses, accelerated cheese ripening; Microbiological spoilage and safety of fermented dairy products; concepts of probiotics, prebiotics, synbiotics, bioactive milk peptides and their application in value addition in fermented dairy products.
Practical
- Isolation of lactic acid bacteria from fermented milks products.
- Examination of purity and activity of starter cultures.
- Preservation of starter cultures by freeze drying and other methods.
- Preparation of concentrated starters and quality evaluation.
- Inhibition of starters by antibiotic residues and other inhibitors.
- Production of bacteriocine by lactic acid bacteria.
- Preparation and quality evaluation of dahi, lassi, yoghurt and kefir
- Examinations of microbial changes during ripening of cheddar cheese
Suggested Readings
- Wood BJ & Warner PJ. (Eds.). 2003. Genetics of Lactic Acid Bacteria. Springer- Verlag.
- Marth EH and Steele JL Applied Dairy Microbiology.Marcel Deker Inn. New York.
- Prajapati, J. B. and Behare, P. V. (2018). Textbook of Dairy Microbiology: Microbiology of Starter Culture Page no. 147-183. Published by Directorate of Knowledge Management in Agriculture, ICAR, ISBN: 978-81-7164-182-6.
- Barbara Speranza, Antonio Bevilacqua, Maria Rosaria Corbo and Milna Sinigaglia (2017). Starter Cultures in Food Production. Wiley Black Well, John Wiley & Sons, Ltd, UK.
- M. T. El-Mansi, C. F. A. Bryce, Arnold L. Demain, A.R. Allman (Edited) (2012) Fermentation Microbiology and Biotechnology, Third Edition CRC.
- Paul McSweeney Patrick Fox Paul Cotter David Everett (eds.) (2017). Cheese – Chemistry, Physics and Microbiology, 4th Academic Press.
Research Laboratories/Units
Molecular Biology Unit (Probiotics, Gut Microbiota and Diversity of fermented milk products ): Dr. Sunita Grover and Ms. Rashmi, H.M.
Molecular Biology Unit (MBU) was created during early 1990s as a centre for carrying out research and teaching activities related to Process Biotechnology. The unit has been able to develop state of the art facility to pursue hard core science in frontier areas of molecular biology and dairy biotechnology with the financial support received from UNDP/FAO, World Bank (NARP), ICAR, Ministry of Food Processing Industries (MoFPI), Department of Biotechnology (DBT) and Indian Council of Medical research (ICMR). Apart from carrying out basic and applied research, the unit is also involved in imparting specialized training in modern molecular biology techniques such as molecular cloning, PCR/Real time PCR (RT-qPCR) techniques, identification of bacteria by molecular tools, tissue culture etc. The focus of the unit is on development of indigenous probiotic strains of Indian gut origin for their application as bio-therapeutic agents by studying their functional efficacy through gene expression in appropriate tissue culture cell lines and animal models. Two indigenous strains of probiotic lactobacilli have been commercialized. The unit has also conducted metagenomic study on the healthy human subjects recruited from north and north east Indian population with entirely different food habits to look at the metagenome of their respective commensal gut microbiota and preponderance of specific phylotypes under different dietary conditions besides gut microbiota profiles of autistic and malnourished children in collaboration with AIIMS and PGI, Chandigarh. The work on diversity profiling of traditional fermented products like ‘dahi’ using metagenomic and culturomic approaches has been initiated.


Anaerobic Microbiology: Dr. A.K.Puniya
The anaerobic laboratory works on the diversity of anaerobic Bifidobacterial spp. and obligatory rumen fungi. The laboratory also conducts research on mitigation of methane emissions from enteric fermentation, metagenomic analysis of reductive acetogens, biomarkers for taxonomy of rumen fungi, direct-fed microbials, etc. Besides, focus is also on the management of life style diseases (i.e. diabetes and obesity) by exploring the role of probiotics (lactobacilli and bifidobacteria), especially through digestive enzyme(s) inhibition, conjugated linoleic/ linolenic acids and/ or development of dairy based functional food(s).

Techno-functional Starter Laboratory (TFSL): Drs. Sudhir Kumar Tomar and Pradip V. Behare
The research area of TFSL is “bio-prospection of native lactic acid bacteria strains for development of techno-functional starters”. Currently, the laboratory is actively engaged in bio-prospecting of native strains for lactic acid bacteria (LAB), their characterization for production of functional bio-molecules (exo-polysaccharides, galacto-oligosaccharides, low calorie sugars, vitamins), proteomic studies of LAB, formulation of single and mixed defined strain starters for fermented dairy foods, stable and active ready to use functional starters as DVS, development of functional fermented dairy foods and cost effective bioprocesses for production of functional metabolites.

Microbial Biosensor, Food Safety and Quality Assurance Laboratory: Dr. Naresh Kumar and Mr. Raghu, H.V.
Quality and safety has become one of the important area of concern primarily because of wide spread outbreaks linked with pathogenic bacteria and their toxins through ready to eat foods including dairy products. Further, food safety standards are constantly under review and new safety standards based on risk analysis are being introduced in codex. Food Safety and Standard Authority of India (FSSAI) has recently introduced new microbiological criteria which includes hygiene indicators (TVC, coliform, YMC) and pathogenic bacteria (Staphylococcus aureus, Bacillus cereus, E. coli, Listeria monocytogenes, Salmonella, Sulphite Reducing Clostridia) for their compliance as two and three class sampling plan for milk and milk products. Our research group is working in the area of food safety and successful efforts have been carried out in the development of sensors for antibiotics, β-lactam group, aflatoxin M1 in milk using bacterial spores as bio-recognition molecules. Similar approaches were also executed to detect L. monocytogenes, E. coli and Enterococci in milk employing markers enzymes. New know- how so generated through external funded projects (MFPI, NAIP, Outreach) were protected through patents and licensed to stake holders in our country for industrial application. Apart from research, state of the art infrastructure facilities which include clean room, BSL-3 containment and testing equipments (EMCCD, SPR, D-Count, VIDAS, Charm system) were also established for execution of inter-disciplinary/ externally funded research projects.

Functional Fermented Foods and Bioactive Peptides: Dr. Shilpa Vij
This cell is actively engaged in the research and development of functional fermented foods and bio-processing of whey into value added products. Processes have been standardized for various fermented dairy and non dairy foods and whey based products. The technologies have been developed for biofunctional fruit yoghurts, soy based yoghurt, soy dahi and whey based functional probiotic beverages. The laboratory is also engaged in production of antimicrobial bioactive peptides from milk protein like whey and casein, and also from soy proteins and biopreservation of dairy products. The laboratory is also involved in the research project on the production of bioethanol from whey using stress tolerant yeasts.

Synbiotic Functional Foods: Dr. Chand Ram
Synbiotic functional foods facility at Dairy Microbiology Division was established in the year, 2009. The laboratory is involved in development of synbiotic functional fermented dairy foods fortified with probiotic, prebiotic and plant bioactive components to prevent diseases in humans as an alternative to antimicrobial treatments. The focus is to identify and understand factors involved in disease initiation, progression and their prevention in vitro and in vivo animal models to improve human health and productivity by preventive healthcare. The research laboratory has developed process technologies for manufacture of probiotic tulsi dahi for cholesterol reduction, synbiotic Misti Dahi and yoghurt with improved food safety and shelf life, blueberry fortified probiotic Dahi for prevention of colon cancer, probiotic direct vat set (DVS/DVI) cultures for short set dahi. Currently, we are focusing on prevention/treatment of non alcoholic fatty liver diseases (NAFLD), bio-transformation of cholesterol for hypocholesterolemic effects, bioremediation of toxic metals, antibiotics and aflatoxins, control of biofilms in dairy niche, food safety and bio-preservation of dairy foods by natural plant bioactive components.

Microbial metabolites and bio-preservation: Dr. Diwas Pradhan
Lactic acid bacteria synthesize a variety of inhibitory compounds, which prevent the development of undesirable bacteria in the fermented foods. Among all the antibacterial substances, bacteriocins offer the best incentive for the preservation and prevention of food spoilage by undesirable microorganisms and are thus unique with respect to their role in the biopreservation of foods. Bacteriocins are small, single or complex proteins or proteinaceous substances. The bacteriocins with a wide inhibitory spectrum are interesting because of their potential to control the growth of spoilage and pathogenic flora. The cell is engaged in isolation of bacteriocinogenic lactic acid bacteria, production, purification, characterization of bacteriocins and their application in bio-preservation besides development of bacteriocins based antimicrobial packaging for enhancing the shelf life and safety.

Central Facilities
National Collection of Dairy Cultures (NCDC) : Dr. Sudhir Kumar Tomar
The National Collection of Dairy Cultures (NCDC) is a national facility being maintained at the Division of Dairy Microbiology since 1960. The NCDC stock includes strains of bacteria, fungi and yeasts. The main interest of the collection lies in the lactic acid bacteria from dairy sources. Besides individual strain cultures, the NCDC also holds mixed strain (traditional) and defined strain-formulated cultures for making different varieties of cheese and fermented milks. The NCDC caters to the need of dairy industry, research organizations as well as educational institutions. It also organizes specialized training programmes and workshops etc. to provide know-how on maintenance and preservation of cultures, propagation of dairy starter cultures and other related aspects. The NCDC is an Affiliate Member of the World Federation for Culture Collections and is also registered with the World Data Center on Microorganisms (registration number WDCM 775). It has also been listed in the World Directory of Culture Collections published by the WDCM, Japan.

Electron Microscopy Centre : Dr. Sudhir Kumar Tomar
The Electron Microscopy Centre of the Division has been established as a central facility for carrying out research in the advanced area of ultra structure of microorganisms and microstructure of dairy foods. The Electron Microscopy Center at NDRI is a core facility providing all levels of technical support and consultation in the area of light microscopy, electron microscopy, and image analysis. The centre is located at Room No.110, G- Floor, Dairy Microbiology Division. It provides microscopy and specimen preparation services for biological and food science research. In addition, the centre offers necessary training and access to all microscopes and ancillary equipment to faculty, staff, and students of different divisions of the NDRI as well as external users. This centre is operated on a cost-recovery basis and fees are accessed for consumables, equipment use, and staff support. The major instruments in the EM Centre include a Scanning Electron Microscope (EVO 18, Zeiss, U.K.), Transmission Electron Microscope (Jeol, JEM-1010, Japan). The ancillary equipment includes Ultramicrotome, Sputter coater and Critical point dryer.

Central Instrument Laboratory: Dr. Chand Ram
Divisional central instrument laboratory is well equipped with various latest equipments viz., Thermocycler, Gel Documentation System, ELISA Plate Reader, Microphotography Microscope, Spectrophotometer, High Speed Centrifuge, Water Purification System, Ice Flecking Machine, Sonicator etc. This facility caters to the needs of faculty, research scholars and students of the division as well as the institute.

National Referral Centre on Milk Quality and Safety : Dr. Naresh Kumar and Mr. Raghu H.V.
National referral centre on milk quality and safety (NRCMQS) with funding under NAIP project was establishment at NDRI in 2014 for addressing the scientific issues on milk safety in our country with the mandate to provide scientific solution in specialized field of milk safety and quality assurance; to carry out Risk Profile Work on Potential Contaminants in milk and milk products; development of milk safety standards, sampling plan and testing procedures for regulatory compliance; Rapid Biosensor Based Tools/Assay/Kits for field application and to conduct training on HRD development on milk quality. State of the art laboratory having equipments such as Biosafety cabinets, VIDAS multiple pathogen detection system, RT- PCR, Multimode plate reader, Centrifuge, Automatic media preparatory cum sterilizer, Biacore Surface Plasmon Resonance system, D count flowcytometer etc.

List of Technologies Transferred During 2013-2018
| Sr. No. | Name of Technology | Revenue (Rs.) |
|---|---|---|
| 2019 | ||
| 1 | Spore based technology for detection of antibiotic residues in milk transferred to M/s. Delmos Research Pvt. Ltd. 5210 / 29, Surat Nagar Phase 1, Gurgaon 122001through MOU signed dated 12 March 2019 | Rs. 3,54, 000 |
| 2 | Technology of Sour Dahi using prolific acidifying lactic cultures to Lacpro Biotech Private Ltd., Pune through Agriinnovate India Ltd. on 19.3.2019 | Rs. 1,50,000 |
| 3 | MistiDoi with fast acidifying high sugar tolerating lactic culture (s) to Lacpro Biotech Private Ltd., Pune through Agriinnovate India Ltd. on 19.3.2019 | Rs. 1,60,00 |
| 4 | Strip based technology for detection of antibiotic residues in milk M/s. Florecer Services Private Limited, New Delhi, 122001through MOU signed through Agriinovate with non-exclusive license fee dated 01 July 2019. | Rs 5,90, 000 |
| 5 | Strip based technology for detection of pesticide residues in milk M/s. Florecer Services Private Limited, New Delhi, 122001through MOU signed through Agriinovate with non-exclusive dated 01 July 2019 | Rs 5,90, 000 |
| 2018 | ||
| 6 | ‘Sugar tolerating lactic culture for preparation of MistiDoi (MistiDoi Culture-20 freeze dried ampoules)’ transferred to NIF Private limited, Kanpur, UP (2×20 ampoules transferred) | 2×1,00,000= 2,00,000 |
| 7 | ‘Sugar tolerating lactic culture for preparation of Mistidoi (Mistidoi culture – 15 Freeze dried ampoules)’ transferred to NIF Private limited, Kanpur, UP (15×3 ampoules transferred) | 75,000×3= 2,25,000 |
| 8 | ‘Sugar tolerating lactic culture for preparation of Mistidoi (Mistidoi culture – 15 Freeze dried ampoules)’ transferred to Schreiber Dynamix Dairies Pvt. Ltd., Pune | 1,60,000 |
| 2016 | ||
| 9 | Technology “Paper strip assay for detection of pesticide residues” was licensed to M/s. Hatsun Agro Product Limited, Chennai MOU Dated 17thDec, 2016, as non-exclusive license for ten years. | 5,75,000 |
| 10 | Technology “Spore based kit for detection of antibiotic residues in milk at dairy farm” was licensed to M/s. Hatsun Agro Product Limited, Chennai MOU Dated 17thDec, 2016 as non-exclusive license for ten years. | 3,45,000 |
| 11 | ‘Whey based medium for lactic acid bacteria’ transferred to, Absource Biologics (P) Ltd., Kinetic Innovation Park, D-1 Block, Plot No. 18/1 Part, MIDC, Chinchwad, Pune – 411019, Maharashtra on 05.02.2016. | 6,87,000 |
| 12 | ‘Bioprocess for Direct Vat Set MistiDahi Culture’ transferred to Absource Biologics(P) Ltd., Kinetic Innovation Park, Chinchwad, Pune – 411019, Maharashtra on 05.02.2016. | 8,01,500 |
| 13 | ‘EPS producing culture for preparation of low-fat Dahi’ transferred toAbsource Biologics (P) Ltd., Kinetic Innovation Park, D-1 Block, Plot No. 18/1 Part, MIDC, Chinchwad, Pune – 411019, Maharashtra on 05.02.2016. | 1,14,500 |
| 14 | ‘Exopolysaccharides producing cultures for preparation of low-fat lassi’ transferred to M/s Renuka Milk & Dairy Product, Ghosikheda, Tehsil Mhow, Indore, Madhya Pradesh.Technology transferred on 10th June 2016 | 1,00,000 |
| 2015 | ||
| 15 | ‘MistiDoi with fast acidifying high sugar tolerating lactic culture’ transferred to – Abis Dairy Farm, Indamara village, Pendri Post, Rajnandgaon Dist., Chattisgarh on 19.05.2015. | 1,79,776 |
| 16 | ‘MistiDoi with Fast Acidifying High Sugar Tolerating Lactic Culture(S)’ transferred to – CP Milk and Food Products Pvt. Ltd. Lucknow, U.P. on 12.11.2015 | -1,82,400 |
| 17 | ‘MistiDoi with Fast Acidifying High Sugar Tolerating Lactic Culture(s) transferred to ITC LIMITED, Virginia House, 37, Jawaharlal Nehru Road, Kolkata – 700 071, West Bengal on 03.12.2015 | 1,83,200 |
| 2014 | ||
| 18 | ‘An indigenous strain of Lactobacillus plantarumLP91’ was transferred to to M/s Sarvotham Care Ltd., Secunderabad through MoU exchange at ICAR, Krishi Bhawan on 30.09.2014. | 10,00,000 |
| 19 | ‘An indigenous strain of Lactobacillus fermentum LF1’transferred to to M/s Sarvotham Care Ltd., Secunderabad through MoU exchange at ICAR, Krishi Bhawan on 30.09.2014. | 10,00,000 |
| 20 | 'A Technology for production Misti Dahi having improved body and texture using well characterized fast acidifying high sugar tolerating lactic culture’ transferred to Namaste India Foods Pvt. Ltd., Kanpur-U.P through MOU exchange on 1. 11.2014 | 1,60,000 |
| 2013 | ||
| 21 | Technology on “Detection of L. monocytogenes in milk” transferred to M/s Neugen Diagnostics (India) Pvt. Ltd., Hyderabad as non-exclusive license with lumsump price of Rs 7.5 lakhs through MOU (ref. no. 11147) exchange vide dated 5.07.2013. | 3,50,000 |
| 22 | Technology on “Detection of Enterococci in milk” transferred to M/s Neugen Diagnostics (India) Pvt. Ltd., Hyderabad as non-exclusive license with lumsump price of Rs 3.5 lakhs through MOU (ref. no. 11146) exchange vide dated 5.07.2013. | 7,50,000 |
List of Patents Granted/Filed During 2013-2018
| Sr. No. | Name of Technology |
|---|---|
| 2018 | |
| 1 | A process for manufacture of low-fat chakka and Shrikhand by using exo-polysaccharides producing bacteria (Filed) |
| 2017 | |
| 2 | A process of preparing a spore inhibition based enzyme substrate assay for monitoring aflatoxin M1 in milk (Granted). |
| 3 | Construction of mutant strain of Kluveromyce smarxianus for enhanced galactose utilization (Filed) |
| 2016 | |
| 4 | Spore germination based Detection Kit for β-lactam group in milk. Patent # 115/DEL/2009. Patent No. 273160 dated 25/05/2016. (Granted). |
| 2015 | |
| 5 | Rapid spore enzyme based miniaturized assay (s) for detection of pesticide residues. Indian Patent Reg. No. 3819/ DEL/ 2015. (Filed) |
| 2014 | |
| 6 | A Novel Process of Sporulation, Activation and Germination in Thermophilic Bacteria for Rapid Detection of Antibiotic Residues in Milk. Indian Patent No. 264145 dated 9.12.2014. (Granted). |
| 7 | Development of Enzyme-Spore based assay (s) for monitoring antibiotic residues in milk Patent: Reg # IPR 2213/DEL/2014. |
| 8 | Spore-sensor for rapid detection of E. coli in milk employing marker enzymes and marker sugar as germinants. Patent: Reg # IPR 2214/DEL/2014. |
| 2013 | |
| 9 | Two Stage Enzyme Assay for Detection of Listeria monocytogenes In Milk Products. Patent # 1357/DEL/2013. |
| In-House Research Projects (IRC) | ||
|---|---|---|
| Sr. No. | Project Name | Project by |
| 1 | Preparation and evaluation of panchmrit for immunomodulation | Dr.ShilpaVij |
| 2 | Evaluation and validation of enzyme substrate based strip test for detection of subclinical mastitis | Dr.Chand Ram |
| 3 | Conducting-polymer based rapid detection of microbial quality of milk | Dr. Raghu H.V |
| 4 | Unveiling the microbial diversity of traditional Indian fermented milk product “Dahi” through culturomic and metagenomic approaches | Dr.Rashmi H.M |
| Externally Funded Projects | ||
|---|---|---|
| Sr. No. | Project Name | Project by |
| 1 | Cell wall components of probiotic lactobacilli as therapeutics for amelioration of inflammatory gut diseases-ICMR | Dr. Sunita Grover |
| 2 | Scheme on Dairy Microbes under Network Mode (ICAR-National Centre on Veterinary Type culture Collection, Hisar, Haryana | Dr.S.K.Tomar |
| 3 | Monitoring of Drug Residues and Environmental Pollutants – ICAR | Dr. Naresh Kumar |
| 4 | Development of Immunomodulatory Exopolysaccharides Containing Healthy Fermented Dairy Foods – MoFPI | Dr. Pradip Behare |
| 5 | Bile responsive proteo-transcriptomics investigation of native probiotic strain Lactobacillus helveticus MTCC-5463 – SERB | Dr. Pradip Behare |
| 6 | Surveillance of Dairy Products for antibiotic-resistant zoonotic bacterial pathogens under field conditions – SERB – ECR | Dr. Raghu H.V |
| 7 | Development of Edible Antimicrobial Packaging Films for Traditional Dairy Sweetmeats using Metabolites of Lactic Acid Bacteria – DST | Dr. Diwas Pradhan |
| 8 | Prevalence of Antimicrobial Resistance in Dairy Lactic Starters in Haryana Region – ICMR | Dr.DiwasPradhan |
| International Projects | ||
|---|---|---|
| Sr. No. | Project Name | Project by |
| 1 | DOSA-Diagnostic for one health and user driver solutions for AMR-DBT-Indo-UK | Dr.Naresh Kumar |
Molecular Biology Unit (Probiotics, Gut Microbiota and Diversity of fermented milk products)
Efficacy of indigenous strains of probiotics for human health
A collection of proven indigenous strains of probiotic lactobacilli isolated from faecal samples from healthy human subjects and other sources was established at NDRI, Karnal under a DBT funded network collaborative project to harness their general and specific health benefits most optimally in the target population. Molecular techniques such as PCR, sequencing of 16S rRNA and housekeeping genes (rpoA, pheS and tuf), RAPD and MLST were developed for the identification of probiotics at genus, species and strain level. MLST (Multi Locus Sequence Typing) Scheme was developed using eight housekeeping genes (pgm, ddl, gyrB, purK1, gdh, mutS, tkt4 and phe) for indigenous probiotic isolates of Lactobacillus plantarum, and established Eleven “Sequence Types”(ST) for Lactobacillus plantarum.
Whole genome sequence of indigenous L. plantarum Lp91, L. fermentum Lf1 and Lbs2
The draft genome sequences of Indigenous probiotic strains MTCC 5690 (Lactobacillus. plantarum Lp91) and MTCC 5689 (Lactobacillus fermentum Lf1) and Lbs2 have been determined.

Deposition of proven probiotic Lactobacillus strains at MTCC under Budapest Treaty for safe deposit and as per ICMR-DBT guidelines
5954. plantarum Lp91, L. fermentum Lf, Lactobacillus casei Lbs2 and Lactobacillus fermentum Lbs4 have been deposited at International repository at MTCC under Budapest Treaty for safe deposit and as per ICMR-DBT guidelines wherein there is a requirement that any probiotic lactobacillus to be commercialized should be deposited in an International repository. The strains names are Lp91 as MTCC 5689, Lf1 as 5690, Lbs2 as MTCC 5953 and Lbs4 as MTCC 5954.
Probiotic attributes and functionality
The probiotic Lactobacillus strains exhibited all the desirable probiotic attributes under simulated gut conditions and exhibited anti-inflammatory potential both in vitro as well as in animal models
plantarum Lp91 expressed hypocholesterolaemic effects in rat model. Lp91 and Lf1 improved glucose tolerance and insulin sensitivity in C57BL/6J male mice fed on high fat diet (HFD) for a period of six months and prevented the development of diabetes.
Two of our potential probiotic strains viz. Lp91 and Lf1 could effectively ameliorate both 2,4,6-trinitrobenzene sulfonic acid (TNBS) and dextran sodium sulfate (DSS) induced colitis in mouse models respectively. The possible mechanism of anti-colitic action by Lp91 included down regulation of inflammatory biomarkers and up regulation of IL-10 by Lp91. L. fermentum Lf1 on the other hand exhibited a protective role in oxidative stress induced colitis.
Gut hormone secretion could be observed using in vitro cell line model of endoenterocrine cells (NCI H716 and STC-1).
The technology of lab scale production of three most popular traditional fermented dairy products viz. dahi, lassi and shrikhand supplemented with Lp91 has been developed.
Cell wall components
It has been recognized that cell wall components as the Microbe Associated Molecular Patterns (MAMPs) not only could help in probiotic adhesion but also elicit specific immune response by interacting with Pattern Recognition Receptors and can act as immunobiotics. Hence, cell wall components like surface proteins, peptidoglycan and lipoteichoic acid have been isolated from probiotics strains and investigated for their anti-inflammatory potential in DSS colitis mouse model. This can pave way for exploring these purified cell surface components for developing into novel pharmabiotics for boosting immunity in immuno-compromised individuals with low tolerance to heavy dose of live cells of probiotic strains.
Anti-inflammatory effect of surface proteins and peptidoglycan of probiotic lactobacilli in colitis mouse model demonstrated that surface proteins may offer a safer preventive and therapeutic option for combating inflammatory disorders
Heat killed cells of probiotic lactobacilli were also found to reduce the inflammatory response through down regulation of the pro-inflammatory cytokine TNF-α secretion both in in vitro cell line and in vivo colitis mouse model.
Diet and Gut Microbiota
Realizing the tremendous importance of the role of indigenous probiotics in human health from Indian perspective, a joint collaborative project on “Comparative metagenome of human gut of North and North-eastern region of India” with financial support from DBT was taken up to study the gut microbiota in north and north east Indian population representing totally different dietary situations with different food habits.

North-Eastern human Gut microbial diversity was studied between vegetarian and non-vegetarian population under different age groups (20-30 and 50-60). No significant gut microbial changes were observed at the phylum and Family level in all the population groups except Enterobacteriaceae and Veillonellaecae which showed higher abundance in the gut microbiota of North-Eastern population compared to North India
Gut microbiota composition was found to be distinctive in Autistic children. Among the four predominant phyla, decreased abundance of Firmicutes phylum and increased abundance of Bacteroidetes, Actinobacteria and Proteobacteria was observed in ASD children.
The comparative analysis of predominating Gut Enterotypes in children of varying nutritional status (malnourished children) showed significant (P<0.05) decrease in the abundance of Bifidobacteria with the decline in the nutritional health of the children using abosolute qPCR quantification approach. Metagenomic and metabolomic profiles of indigenous dairy cattle and fermented milk products
Work has been initiated to investigate the metagenomic and metabolomic profiles of indigenous dairy cattle under different dietary regimens and to uneveil the metataxonomics of dahi- an Indian traditional fermented product used in different parts of country
Anaerobic Microbial Fermentation
The anaerobic microbiology lab has been working on the diversity of obligately anaerobic rumen fungi, development of biomarkers for improving their taxonomy, mitigation of enteric methane using various approaches and administration of direct-fed microbials for improving the animal productivity. Besides, our research group also explored the role of probiotics, especially through digestive enzyme(s) inhibition and conjugated linoleic/ linolenic acid production.
Research Achievements:
- In our research group, we have reported two novel genera of anaerobic fungi (Oontomyces anksri & Buwchfawromyces eastonii), which were only the 7th & 8th genera since their discovery in mid-seventies.
- Developed a method for differentiation of genera/ species of these fungi using D1/D2 domain of large-subunit r-DNA. Our research group also developed the formulation of most-efficient direct-fed microbials that improved animal nutrition & productivity.
- Contributed towards understanding the diversity of methanogens and methane-mitigation interventions. Our research group also isolated health-promoting probiotics that produces conjugated linoleic/ linolenic acids, transform isoflavones or control postprandial hyperglycemia.
- Our research group also developed technologies like ‘methods for long-term preservation of anaerobic fungi’; ‘micro-encapsulation of probiotics’; ‘method for detection of antibiotics in milk’; and ‘SSF-ENLAC technology’.

Neocallimastix sp.

Anaerobic fungi growing on rice straw

Anaeromyces sp.
Techno-Functional Starters Lab (TFSL)
Scheme on Dairy Microbes under Network Mode-VTCC
A total of 655 lactic cultures have been isolated from dairy and non-dairy samples and after identification were deposited in VTCC culture bank. These cultures have been evaluated for technological and functional properties. Pediococcus cultures with galactose utilization, phytase activity, EPS producing, probiotic and antimicrobial activity have been characterized.

More than 100 lactic cultures from cold dessert region have been isolated and characterized. Lactococcus lactis cultures used for preparation of Dahi and Gouda cheese showed overall better acceptability in terms of less bitterness, more flavour production, better compatibility and characteristic eye formation.

Production of extracellular Vitamin B12 by lactobacilli and ameliorative effect of vitamin B12 bioenriched soy based functional food on adverse pregnancy outcomes of Wistar rat
Vitamin B12 producing lactobacilli (L. plantarum F2, V7, F9, and L. rhamnosus F5) have been isolated from infant’s fecal sample. Lactobacillus plantarum F2 endowed with highest extracellular vitamin B12 production Developed vitamin B12 bio-fortified soy-curd with Lactobacillus plantarum F2 contains appreciably higher vitamin B12 than other soy-fermented foods. Vitamin B12 produced by Lactobacillus plantarum F2 was bioavailable and ameliorate the adverse pregnancy outcomes in wistar rats

Bioprocess for bioactive peptides from whey
Bio-process for bioactive peptides production from whey was developed for formulation of functional food. Bioactive peptides (3-1 kDa fractions) have shown highest ACE and alpha-glucosides inhibitory activity in vitro.
Proteome analysis of Lactobacillus strains in response to stresses
Acid and bile responsive differential proteome changes in L. fermentum strain at pH 2.5 have been investigated by LFQ technique. Bile responsive proteome changes in L. fermentum NCDC 400 and L. helveticus MTCC 5463 have been investigated by high throughput mass spectrometry techniques. Proteins involved in protein and carbohydrate metabolisms were highly up-regulated in Lactobacillus strains. Genome analysis of NCDC 400 revealed large number of hydrolase family genes which might assist this strain to overcome deleterious effect of bile.

Acid responsive DEPs in NCDC 400

Differential Expression Analysis (Control Vs 1.2%) bile treated

Draft genome of NCDC400
Cholesterol Binding Exopolysaccharides from Lactic Acid Bacteria
Cholesterol binding exopolysaccharides “EPS 400” from Lactobacillus fermentum NCDC 400 has been characterized. EPS400 @ 2% showed maximal binding of cholesterol (90.32±0.2%) in vitro without affecting stability at low pH. Feeding of EPS 400 to Hypocholesterolemic rats showed about 16.5% total cholesterol reduction in serum, 17.41% in liver and 12.17% adipose tissue. EPS 400 exerted significant hypocholesterolemic effect on rats fed with cholesterol diet.

Functional Fermented Foods and Bioactive Peptides
Bioactive peptides
Among all the species, sheep milk derived peptides in 10kDa fraction showed maximum antimicrobial activity followed by cow and buffalo milk. Higher antioxidant and antihypertensive activity were seen in sheep milk peptides in 5kDa fraction followed by cow and buffalo milk.
ACE inhibitory peptides sequence identified in fermented milk-derived peptides are VRGPFPIIV, IPYVRYL (ovine), AVPYPQR, (camel), FLPYPY., KAVPYPQR, LPYPY PQKAVPYPQ (caprine). Peptides with Antioxidant activity is AVPYPQR (Ovine), SRYPSYGIN (camel) and PQQVSALPPPPMQY (caprine). Potent antimicrobial peptides QPKTKVIPYVRYL, YQEPVLGPVRGPFPII, IPIQYVL, LYQEPVLGPVRGPFPII (ovine) PVVVPPFLQPE, (caprine) and immuno-modulatory activity YQEPVLG (ovine, caprine and camel).


HPLC chromatogram of A. Goat milk B.Sheep milk derived peptides
plantarum C2 fermented soya milk derived bioactive peptides had antimicrobial, ACE-Inhibitory and anti-oxidative properties in 10 kDa peptide fractions.



Functional fermented foods
The fermented productPanchamritwas optimized by using Dahi and milk (2:1) and addition of honey, sugar and ghee and was stable for 4 weeks. Panchamrit had antimicrobial and immunomodulatory activity as observed in HT-29 cell line and was stable for 4 weeks.

Flow Chart for preparation of Panchamrit
NCDC 144 yoghurt culture was used for blueberry fortified synbiotic fruit yoghurt preparation. 10 kDa peptidefractionsfrom the fruit yoghurt showed the highest antioxidant activity (2076.02 µmol/liters TEAC) which was retained up to 20th days of storage (1925.84 µmol/liters TEAC) at refrigeration temperature. The antimicrobial activity (expressed in the zone of inhibition which ranged from 15.53±0.12 to 25.10±0.35 mm).
LC-MS/MS-MS sequencing of 10 kDa bioactive peptide fractions from yoghurt showed many peptide sequences like antioxidant peptides VPYPQ, AVPYPQR, KVLPVPE, VLPVPQKKVLPVPQK, GVRGPFPII, GPVRGPFPII, IPIQY, IPIQYVL, KVLPVPQ, VKEAMAPK and GVSKVKEAMAPK. ACE-Inhibitory peptides, antimicrobial peptides, immuno-modulatory peptides, anti-cancerous peptides and anti-thrombotic peptides were also identified.

Biofunctional Yoghurt
Soymilk supplemented with curcumin (@ 0.04%) and fermented with. L. acidophilus NCDC195 (LA195) and S. thermophilus NCDC323 (YC323) exhibited antimicrobial activity against a broad spectrum of pathogens and antioxidant activity (989.70 TEAC (μM)).

Curcumin Soy whey drink
LR28 showed maximum folate production (23.03±2.0 µg/l)at 2% inoculum level at 100 rpm in 48 h.Lactobacillus reuteri LR28 produced enhanced concentration of folate (35.12±0.92 µg/L) by the addition of 3% lactose, 5.5mg/l PABA and 300ul melon juices in skim milk. Lactobacillus reuteri LR28 showed significant improvement in diarrhea control in vivo.
LAB can be an effective method for preventing or treating hyperuricemia as some of the LAB has purine nucleosides degrading ability. Eleven isolates were positive for purine nucleoside degradation ability.

Intestinal Fluid Antibodies (IgA) by ELISA

Haemoglobin in Animals
Biopreservation
Antimicrobial active film was prepared by coating the antimicrobial peptides and AFS produced by lactobacillus cultures (C25+195) in combination. The shelf life of market khoa was enhanced by 5 days inan active glassine paper and Al-foil. The shelf life of NDRI khoa sample wrapped in active Aluminium foil was enhanced by 10 days and in glassine paper by 5 days.

Antimicrobial film
Bacteriocin like substance of 4-5 kDa peptide was produced by Lactococcus lactis sp. lactis C63. Maximum bacteriocin activity was in MRS broth after 22 h incubation at pH 6.5 and 7.Micro-encapsulation of bacteriocins was done for its controlled release for preservation of Khoa and paneer.
Whey Utilization
The deletion of the two regulatory genes was employed in K. marxianus using the Cre-LoxP system for the efficient utilization of both glucose and galactose by preventing the catabolite repression. The engineered strain in concentrated whey yielded 47 g/L of ethanol during fermentation of concentrated whey containing 100 g/L of lactose which is 19% higher than the parental strain.


Deletion cassette of 2242 bp
Kluyveromyces marxianus MTCC 1389 tolerates sugar (lactose) up to 200 g/L, ethanol up to 6% and thermotolerant up to 45oC. Fermentation with adapted K. marxianus MTCC 1389 strain in 3L bioreactor resulted in final ethanol titer of 79.33 ± 0.82 g/L which was nearly 17.5% more than parental strain 65.66±0.12 g/L. Adapted strain was found stable even after 10 cycles of fermentation in whey (50g/L).
Trehalose contents from Kluyveromyces marxianusMTCC 1389 were found to be higher in osmotic stress i.e. 190 mg/g cell dry wt. and 121 mg/g cell dry wt. under NaCl (0.25M) and lactose (15% w/v) stress, respectively as compared to oxidative stress (100 mg/g cell dry wt.). Viability was also found to be higher at 0.25M NaCl and (15% w/v) lactose. The results of the study suggested that the trehalose plays a protective role primarily in osmotic stress.

Evolution of K. marxianus 1389 cultures with concentrated whey 200 g/L
The biocatalyst β-galactosidase produced by lactose fermenting yeast 6C17 and 6C18 was immobilized on chitosan macroparticles using glutaraldehyde as a crosslinking agent with maximum immobilization yield of 97.4%.The immobilized enzyme retained 89% catalytic activity after 15 cycles of reuse. β-galactosidase was immobilized on chitosan and S. cerevisiae on calcium alginate for efficient use.

Lactose hydrolysis and ethanol production by immobilized S.cerevisiae along with chitosan immobilized β-galactosidase
Synbiotic Functional Foods and Bioremediation
- Process for blueberry fortified probiotic Dahi has been developed. The efficacy has been evaluated for prevention of colon cancer in rat model. The developed fermented product inhibits DMH induced colon carcinogenesis as compared to normal Dahi.

- Identified and evaluated efficacy of probiotic lactobacilli for prevention/treatment of non alcoholic fatty liver diseases in animal model. Feeding of probiotic fermented milk and cultures prevent non alcoholic fatty liver in mice w.r.t. genetic and biochemical markers.
- Identified novel strain of probiotic lactobacilli for biotransformation of cholesterol to coprostanol which reduce its deposition in body thus improve cardiovascular health in animal model.


Gas chromatograms of cholesterol to coprostanol bio-converters L. plantarum HIF 81
- Characterized probiotic strains of lactobacilli to mitigate aflatoxins M1 menace.
- Biofilm forming bacteria have been isolated and characterized from dairy niche to develop strategies for biofilm control in dairy process lines.
- Sulphate reducing anaerobes have been identified to mitigate methane emission.
- Gene sequence of probiotic (6) and sulphate sequestering anaerobic bacteria (20) have been submitted to databank NCBI.
- Identified natural bio-molecules for their bio-preservative potential against food borne spoilage and pathogens including E. coli O157: H7 and Listeria monocytogenes in indigenous fermented (sweetened Lassi) and non fermented dairy (Paneer) products.


Transmission electron micrographs of L. monocytogenes ATCC 15313 (A) Untreated (B) trans-cinnamaldehyde treated
Microbial Biosensor, Food Safety and Quality Assurance Laboratory, National Referral Centre
Development of biosensor based diagnostics in the field of Food Safety and Quality Assurance at National Referral center on milk quality and safety (BSL-3), Dairy Microbiology division
Dairy Microbiology Division took a lead in establishing National Referral Center on Milk Quality and Safety (NRCMQS) with funding under World bank funded NAIP project with fund support of 17.5 Crores in 2014 for addressing the scientific issues on milk safety in our country with the mandate to provide scientific solution in specialized field of milk safety and quality assurance; to carry out Risk Profile Work on Potential Contaminants in milk and milk products; development of milk safety standards, sampling plan and testing procedures for regulatory compliance; Rapid Biosensor Based Tools/Assay/Kits for field application and to conduct training on HRD development on milk quality. State of the art laboratory having BSL-3 facility along with other equipment’s such as Biosafety cabinets, VIDAS multiple pathogen detection system, RT- PCR, Multimode plate reader, Centrifuge, Automatic media preparatory cum sterilizer, Biacore Surface Plasmon Resonance system, D count flow cytometer etc.

BSL -3 Containment Established at NRC
With the established facility at NRC, rapid sensors were developed for detection of potential contaminants in dairy food chain by exploring bacterial spores as biosensor. A large number of biosensor platforms have been developed for rapid on-site, real-time detection of various contaminants in food chains, however, their realization in commercial application is very low primary because of huge cost of either bio-recognition element or transducer involved in the development of biosensor. Bacterial Spore as innovative approach for its application as bio-recognition element was successfully employed in rapid detection of antibiotic, pesticides and bacterial contaminants in dairy foods and their commercialization under field condition.
Spores are dormant structures produced by a process of sporulation in a few species of both gram-positive and gram-negative bacteria such as Bacillus and Clostridium. They are meant to survive unfavorable environmental conditions. Using spore-based biosensors for detection of varying range contaminants offers many advantages over existing methods. These developed biosensors are highly sensitive, reliable, user-friendly, cost-effective and with long shelf life. These contaminants may include different groups of antibiotics, pesticides, heavy metals, pathogenic microorganisms and several others that may be important for public health. Spore-based sensing technologies were developed to target many emerging contaminants in different types of food matrices, including milk and milk products in order to ensure food safety and quality.
Different types of approaches were attempted for the development of spore-based biosensors for detection of antibiotic, pesticides and bacterial contaminants in milk. A proof of concept for the detection of β lactam group of antibiotics in milk which works on the induction of β-lactamase enzyme in germinating bacillus spores. The concept was transformed on Paper strip for specific detection of β-lactam group of antibiotics as specified in CODEX/FSSAI standards in milk. The concept was transformed it into Microfluidic device in collaboration with University of Southampton, UK.
Spore based concept for detection of β –lactams group in milk:
Fabrication of Paper based pillar array device: A paper-based pillar array device for the detection of ß-lactam group of antibiotics in milk was fabricated at the University of Southampton. The device was designed using AutoCAD and 2 mm (diameter) pillars were micro milled on a PMMA surface (1 mm height). The dimensions of the chip were 14 x 14 x 3 mm (width x length x height). Filter paper (whatman Grade 3) was cut into 2mm (diameter) and fixed on the pillar via a double sided tape. The substrate was then pipetted onto the paper (2 µL) and dried in an open air for 5 min. The step by step fabrication of the device is shown in Figure below.

Schematic of the paper-based device for detection of Beta-lactam antibiotics in milk

Photograph of the paper-based device (UK 5 pence coin)
Evaluation of fabricated device with pure β lactamase enzyme and its substrate: A paper-based pillar array device for detection of ß-lactam group of antibiotics in milk was fabricated at the University of Southampton during the visit. After fabrication of device, the working of the device has been tested with pH indicator and ß-lactamase with its substrate for the proof of concept. The device was found suitable for the reactions and proves the concept by using this device for multiple sample analysis in a single trial.
Paper-based pillar array devices




Validation of Paper based pillar array device with spore based paper strip: Milk samples were spiked with amoxicillin antibiotic and mixed with spores and nutrients to induce ß-lactamase production in germinating spores. Samples were loaded onto the container consisting of 2.4 mm wide and 2.4 mm deep wells and incubated at 37° C for 30 min, pillar chip was dipped into the samples (30 min incubation with substrate) and photos were taken as shown in Figure below. The detection of antibiotic was also tested by paper strips developed at NDRI, India and a great agreement was found between these two methods.

Photo showing incubation of nitrocefin (1mg/mL) coated paper with different concentrations of amoxicillin (1- 0 ppb; 2 – control milk; 3- 1 ppb; 4- 2 ppb; 5- 3 ppb; 6- 4 ppb; 7- 5ppb; 8 and 9- 10 ppb)

Representative examples of the same samples
These preliminary results indicate that further development of the paper-based device would lead towards the development of the quantitative tool for antibiotic detection in milk samples and hence, combating microbial drug resistance. This simple to fabricate and easy to operate inexpensive device along with smartphone detection has the potential to revolutionize the point-of care diagnostics industry for animal healthcare and antimicrobial resistance prevention in humans.
Paper Strip Based concept for Detection of Antibiotic Residues in Milk: Paper-based sensors are new alternative technologies for fabricating simple, low-cost, portable and disposable analytical devices for many application. The major advantages of using paper as a sensing platform include ease of availability, low cost, passive liquid transport, compatibility with chemicals/bio-chemicals and fast response. With these basic properties in mind, spore-germination inhibition based assay for antibiotic detection was developed on paper strip for exploring its potential under field application. The stages involved in developing paper sensors includes the proper choice of paper, fabrication/patterning and semi- quantitative analysis based on color development as a result of specific marker enzymes released during spore germination .The test involves pre-dipping of strip in milk and germination of spores in presence of germinant mixture when incubated at 64o C for 1:15 hrs. Development of blue color on paper strip indicates absence of antibiotic residues and no color development indicates presence of antibiotic Residues in milk.

Paper Strip Based concept for Detection of Antibiotic Residues in Milk
Paper strip based assay for antibiotics detection in milk, was validated by third party through an open tender and M/s. Dove Research and Analytics, Panchkula(A unit of Dove Chemicals) validated the claims of the technologies, in terms of working test procedure, sensitivity against various groups of antibiotics as per Limits of Detection (LODs). Certificate no DRA/NDRI/16-17/080217 /002 dated9-2-2017. Patent of the technology has been published (2213/DEL/2014) in IPO Journal no. 07/2016, U/S 11A dated 2016/02/12. Technology MOU was signed on Technology entitled Paper strip for detection of antibiotic residues in milk under outreach project funded by ICAR. M/s. Florecer Services Private Limited, New Delhi, adopted technology through agri inovate with non-exclusive license fee of Rs.5.90 Lakhs+ 2% Royalty dated 01 July 2019.
Spore Based Kit for Detection of Antibiotic Residues in Milk at Dairy Farm: The developed technology is working on principle of spore germination and its inhibition in presence of antibiotic residues in milk. In case when antibiotic residues are absent in milk, marker metabolites are released during germination which change the color of the indicator. However, in presence of antibiotic residues in milk, the spore germination process is inhibited at ≥ MRL level of contaminants and no change in color indicates the presence of drug residues in milk when incubated at 64oC for 2.30 hrs.

Kit for Detection of Antibiotic Residues in Milk at Dairy Farm
Spore based kit for detection of antibiotic residues in milk at dairy farm was validated by third party through an open tender and M/s. Dove Research and Analytics, Panchkula (A unit of Dove Chemicals) validated the claims of the technologies, in terms of working test procedure, sensitivity against various groups of antibiotics as per Limits of Detection (LODs). Certificate no DRA/NDRI/16-17/080217/001dated9-02-2017. Patent on this technology was granted (No: 264145) dated 9.12.2014.the technology was commercialized to M/s. Neugen Diagnostics India Pvt. Ltd., Hyderabad with license fee of 2.5 lakhs on 17th Dec 2008; M/s. Hatsun Agro Product limited, Chennai on 17th Dec 2016. With license fee of 3.0 lakhs and M/s. Delmos Research Pvt. Ltd. 5210 / 29, Surat Nagar Phase 1, Gurgaon 122001 adopted technology through Agri inovate pvt ltd , New Delhi and MOU signed dated 12 March 2019 with an revenue of Cost of technology: Rs. 3.0 Lakhs + 18% GST) Rs. 3.54 Lakhs.
Paper Strip based concept for Rapid Detection of Pesticide Residues: Pesticides are well known carcinogen and their impact on human beings and presence in different food products including milk are well known in the prior art. The existing conventional chromatographic methods (LC/GC-MS) are time- consuming and laborious. Currently, new standards for pesticides have been developed by FSSAI and implemented for regulatory compliance in different food products including milk. For routine monitoring of pesticides under field application, three stage assay on paper strip has been developed based on “spore germination and enzyme inhibition principle”. In case where analyte i.e. pesticide is absent, specific marker enzyme (s) are produced by spores during germination which will act specifically on chromogenic substrate resulting in colored end product on paper strip, whereas complete inhibition of marker enzyme will take place when pesticides are present in food sample (Patent Reg. 3819/DEL/2015).Simple and cost- effective technology for field application for testing of pesticides residues in milk, cereal based foods, fruit juices, feed, fodder, soil, water, manure etc.

Paper Strip based concept for Rapid Detection of Pesticide Residues
Third party validation of developed sensor work on paper strip based assay was carried out at NABL accredited SGS laboratory, Gurgaon by spiking different pesticide groups in reference reconstituted milk (pesticide free milk) in duplicate at 3 different concentrations. The results obtained with developed assay which includes extraction of pesticides from milk and its detection by paper strip based assay and comparative analysis with GC-MS/MS, LC-MS indicated similar results by both the methods. The limit of detection (LODs) as claimed were found reproducible during validation work. No false positive or negative results were observed. Certificate no ref no gg17-001563.001 dated 20-4-2017.The patent of the technology has been published in Indian Patent journal (No. 3819/ DEL/ 2015) no 21/2017 dated 26 May 2017. Technology was commercialized to M/s. Hatsun Agro Product Limited, Chennai adopted the technology through MOU Dated 17th Dec, 2016, exchanged during NDRI industry meet dated 17th Dec 2016 witha non-exclusive license with an amount of Rs. 5, 75,000.00 and subsequently transferred to M/s. Florecer Services Private Limited, New Delhi, adopted technology through agri inovate with non-exclusive license fee of Rs.5.90 Lakhs+ 2% Royalty dated 01 July 2019.
Spore Based concept on Biochip for Listeria monocytogenes, Enterococci and E.coli in milk: A miniaturized spore based assay for detection of bacterial contaminants in milk on functionalized gold chip with minimal quantity of milk and other reagents with enhanced sensitivity was developed. The developed assay was integration with other consortia partners to have multi-analyte high throughout put analysis for dairy applications. The spore enzyme assay was evaluated on biochip using EMCCD camera. The fluorescent signals were quantified in terms of integrated optical density (IOD).Patent on the technology has been published in IPO (1357/ DEL /2013) in Indian patent journal no. 50/2014, Dated12/12/2014

Spore based concept for detection of E. coli on chip

Spore based concept for detection of L. monocytogenes on chip
Third Party Validation: SGS Referral Laboratory, M/s SGS India Pvt. Ltd., Gurgaon, validated Technology was validated by conducting different trials for false positive/false negative results and the working performance of two stage enzyme based for detection of L. monocytogenes within real time of26±0.15+4=30.30±0.15hrs.wascomparedwith ISO 11290 Part-1 1996 method (7-days protocol) and results were found in accordance with the claimsofthedevelopedenzymebasedassayVide Ref No Job No Gg 12-009772.001Dated 9/11/2012. Technology on Listeria monocytogenes and Enterococci were licensed to M/s. Neugen Diagnostics India Pvt. Ltd., Hyderabad with revenuegenerationof7.5lakhsand 3.5 lakhs dated 5thJuly, 2013 respectively.

Surface Plasmon Resonance based detection of Listeria monocytogenes
Surface Plasmon Resonance (SPR) method for the detection of Listeria monocytogenes was optimized using Wheat germ agglutinin (WGA) lectin with a detection sensitivity of 3.0 log cfu/ 100µl in buffer and milk system, respectively. Developed SPR has shown minimum false positive and negative reaction with other G+Ve and G-ve bacteria with the detection time of around 20-30 min, respectively.
Surface Plasmon Resonance based detection of Listeria monocytogenes using Wheat Germ agglutinin
- Protocol for synthesis of Polyaniline-pectin conducting polymer particles was optimized and the particles were characterized using FT-IR and particle size analyser using Zeta-size analyser. A paper strip based assay has been developed using PANI-PEC particles immobilized paper strips for the detection of E. coli and coliform in milk using newly developed ECS medium and CSM, respectively with the a detection limit of 0.5 log cfu/100 µl within a time period of 10 ½ hrs. A paper strip based assay has been developed using PANI-PEC particles immobilized paper strips for the detection of total microbial load in milkin milk using newly optimized medium with a detection sensitivity in the range of 0.5 to 8.5 log cfu/ 100ul and with a detection of time of 5-6 hrs using newly optimized broth medium.

- Surveillance of antibiotic resistant E. coli in milk supply chain was undertaken in our lab and E. coli isolates have shown resistance towards cefepime, gentamicin, erythromycin, trimethoprim, chloramphenicol, ciprofloxacin, tetracycline and 4 among these isolates have shown resistance to ESBL antibiotics (harboring the CTX-M gene).
Prevalence of ESBL positive E. coli in milk
- Protocol for the synthesis of magnetic molecularly imprinted polymers based on iron magnetite encapsulated polymer of methacrylate (monomer) and ethylene-glycol-di-methacrylate (monomer-cross-linker) for selective extraction of captan pesticide from natural sample. Magnetic molecularly imprinted polymer mediated enzyme inhibition based microtiter assay for the detection of Captan pesticide has been developed with a LOD of 0.1 ppb and 88.61±0.22% recovery of captan pesticide in water samples.

Determination of recovery of captan from water, skim milk and pasteurized milk by HPLC using MMIP


Dr. Shilpa Vij
Principal Scientist and Head
Dairy Microbiology Division
In-charge, Molecular Biology Unit
ICAR- National Dairy Research Institute
Karnal-132001 (Haryana)
INDIA
Phone: 91-184-2259180/2259168 (0)
Fax: 91-184-2250042
- Back to previous page
- |
-
Page last updated date:21-03-2025 06:45 PM












